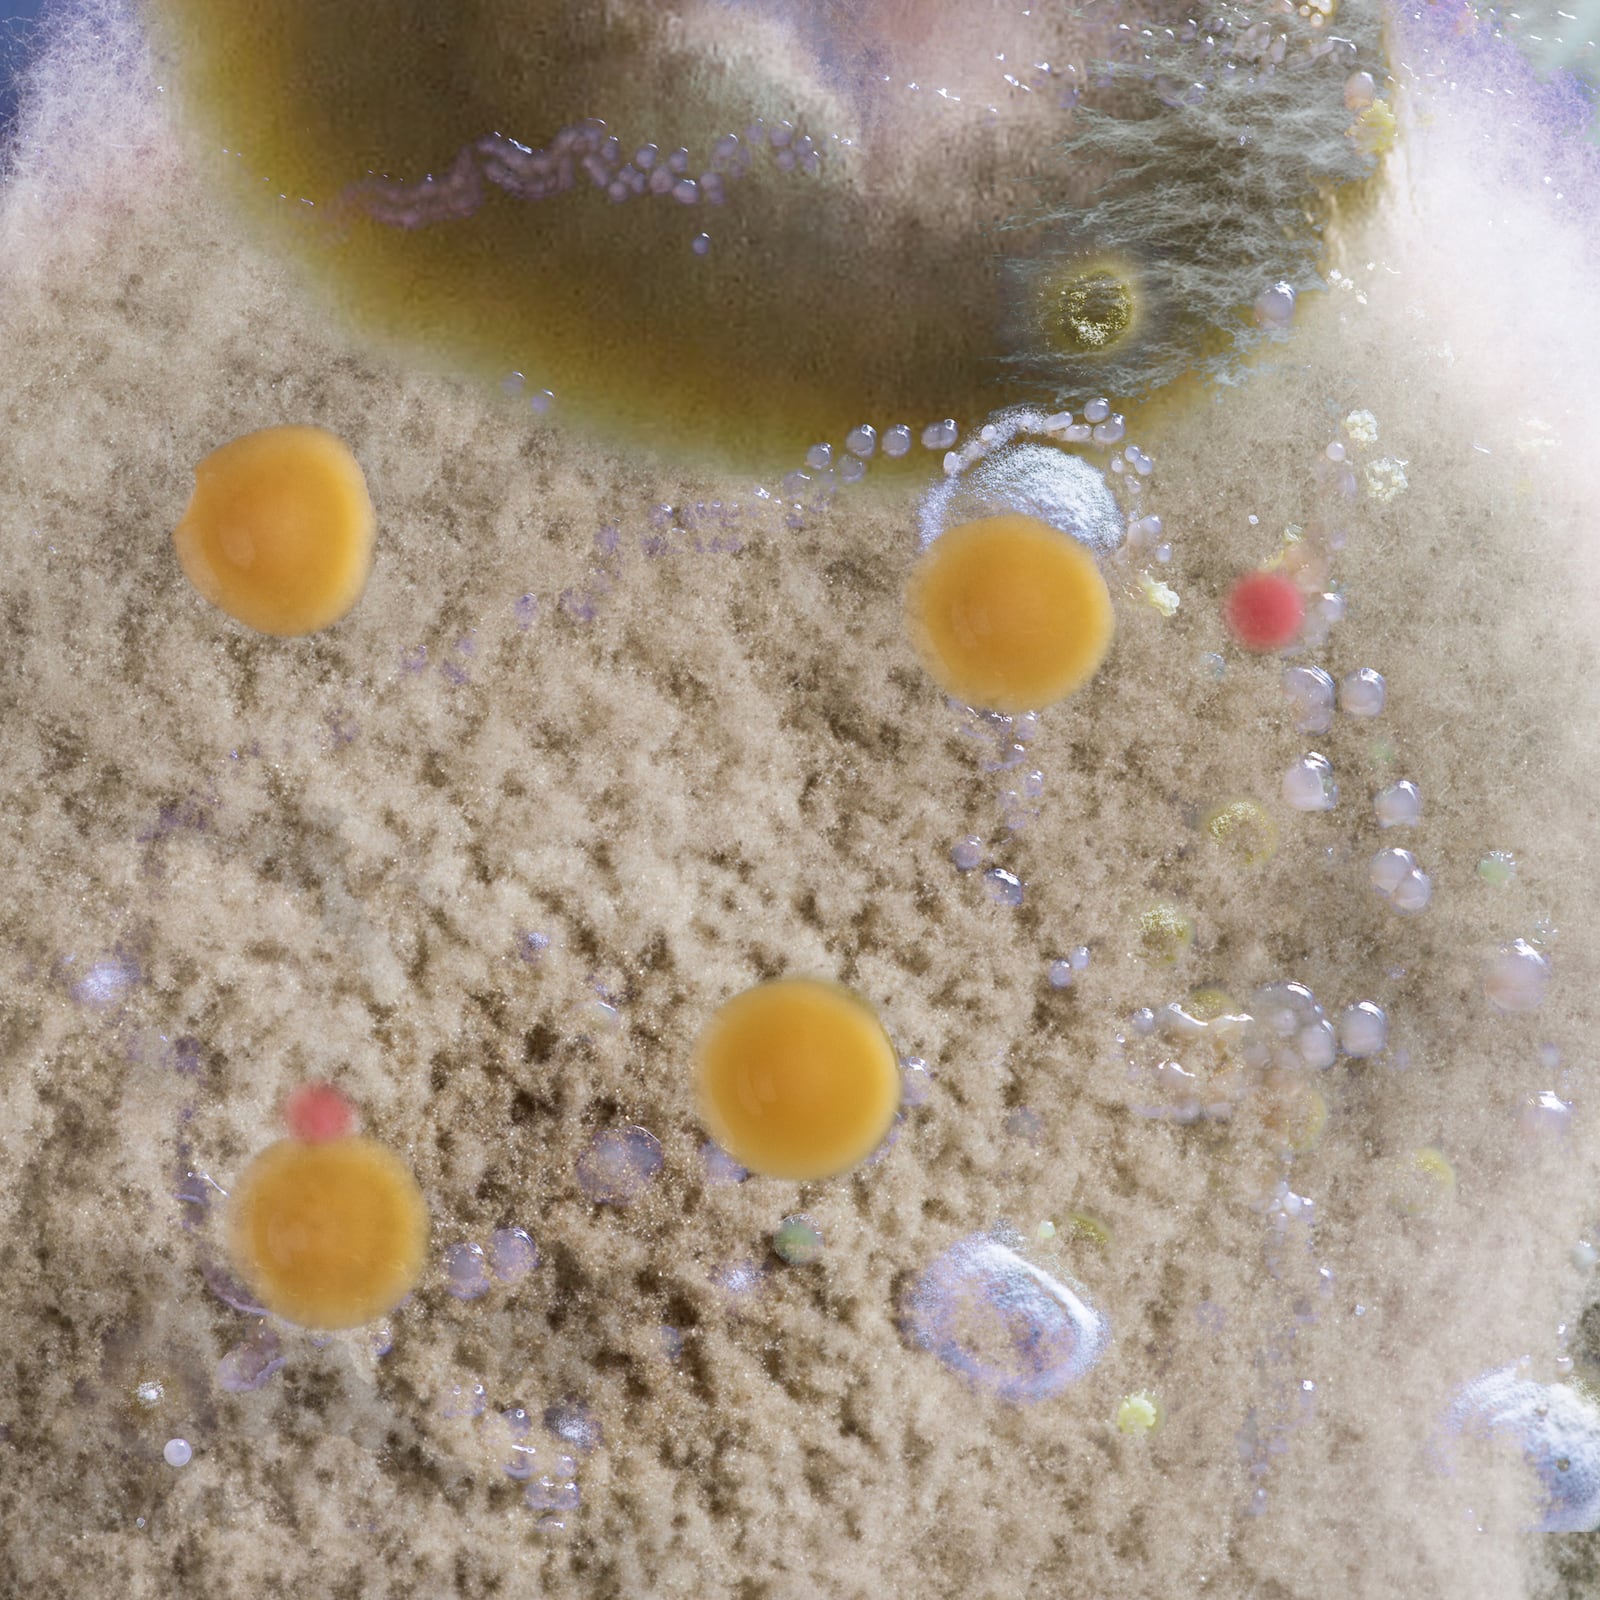

laboratoire écologie et art pour une société en transition
media
filter media by
-
Reading
-
Video
-
Audio
- press
- All media
Cruel optimism
Reading
“Cruel optimism”, according to Lauren Berlant, refers to what grates on our desires and prevents us from carrying on as hoped
least

The Nest
Reading
A poetic reflection by Gaston Bachelard on the nest as a symbol of intimacy, refuge, and imagined worlds.
CROSS FRUIT (ex Verger de Rue)
Faire commun
Se rencontrer sur le seuil
Everything Flows
Reading
Life relies on a delicate synchronization between the rhythms of living beings and the cycles of the Earth.
Faire commun
Vivre le Rhône
CROSS FRUIT (ex Verger de Rue)
Walking in Taranto
Reading
To encounter a city through walking.
least
The “life” of objects
Reading
Matter should not be considered as passive and inert, but as infused with intrinsic vitality.
d'un champ à l'autre / von Feld zu Feld
Peau Pierre
Emergency and Cocreation
Reading
An interview with architect Antonella Vitale.

Living Soil
Reading
Although we walk on it every day, we rarely consider the importance of soil in our lives.
CROSS FRUIT (ex Verger de Rue)
Faire commun
Arpentage
Fences and Power
Reading
The fruits of the earth belong to us all, and the earth itself to nobody.
Arpentage
Faire commun
d'un champ à l'autre / von Feld zu Feld
Se rencontrer sur le seuil
Autumn in the Garden
Reading
“We say that spring is the time for germination; really the time for germination is autumn”.
CROSS FRUIT (ex Verger de Rue)
Faire commun
Arpentage
How happy is the little stone
Reading
Emily Dickinson celebrates the happiness of a simple, independent life.
Peau Pierre
Arpentage
Faire commun
d’un champ à l’autre / von Feld zu Feld
Ô noble Green
Reading
The «Ignota Lingua» by Hildegarde of Bingen.
CROSS FRUIT
Common Dreams
Faire commun

The Multiciplity of the Commons
Reading
Yves Citton discusses commons, negative commons, and sub-commons with us.
Common Dreams Panarea: Flotation School
Faire commun
Arpentage
CROSS FRUIT
Experiencing the Landscape
Reading
The complexity of the term ‘landscape’ can best be understood through the concept of ‘experience’.
Vivre le Rhône
Faire commun
Arpentage
CROSS FRUIT
Se rencontrer sur le seuil
Heidi 2.0
Reading
The Alps and “proximity exoticism.”
Arpentage
d’un champ à l’autre / von Feld zu Feld
Listenting to the Sourdough
Reading
An interview with the artist and scholar Marie Preston on cooperative practice and including the more-than-human.
Common Dreams Panarea: Flotation School
Faire commun
Mineral Life
Reading
Recognising our entanglement with geological processes.
Peau Pierre
Rethinking Transition
Reading
An interview with Denise Medico.
Peau Pierre
CROSS FRUIT (ex Verger de Rue)
Video
An urban ecology project that involves citizens in the design, creation and maintenance of an orchard.
CROSS FRUIT
Vivre le Rhône: part 3
Video
River Guardians
Vivre le Rhône

The Sacrifice Zone
Reading
“One day, at the Ironbound Community Corporation, we smelled something pungent”.
least
The Gesamthof recipe: A Lesbian Garden
Reading
The Gesamthof is a non-human-centred garden, a garden without the idea of an end result.
CROSS FRUIT
Peau Pierre
Peau Pierre: an audio capsule
Audio
“When our skins finally touch, water is the intermediary in this encounter”.
Peau Pierre
Wild Bread
Reading
An essay about the experience of hunger in Europe in the modern age.
Faire commun
CROSS FRUIT


Vivre le Rhône: the podcast, part 03
Audio
An audio project tracing the experiences of those who have come closer to the river by walking.
Vivre le Rhône
Vivre le Rhône: the podcast, part 02
Audio
An audio project tracing the experiences of those who have come closer to the river by walking.
Vivre le Rhône
Spillovers
Reading
A sci-fi essay and sex manual created by Rita Natálio.
Peau Pierre
Vivre le Rhône: part 2
Video
When art meets law.
Vivre le Rhône
Guardians of Nature
Reading
An interview to Marine Calmet, lawyer specialised in environmental law and Indigenous peoples’ rights.
Vivre le Rhône
Bodies of Water
Reading
Embracing hydrofeminism.
Vivre le Rhône
Common Dreams
Peau Pierre
Faire commun

Intimity Among Strangers
Reading
Lichens tell of a living world for which solitude is not a viable option
Common Dreams
Faire commun
CROSS FRUIT
Vivre le Rhône: the podcast, part 01
Audio
An audio project tracing the experiences of those who have come closer to the river by walking.
Vivre le Rhône

A Sub-Optimal World
Reading
An interview with Olivier Hamant, author of the book “La troisième voie du vivant”.
Common Dreams
CROSS FRUIT
Faire commun

Learning from mould
Reading
Even the simplest organism can suggest new ways of thinking, acting and collaborating
Common Dreams
Peau Pierre
CROSS FRUIT
Faire commun
Arpentage
d’un champ à l’autre / von Feld zu Feld
Putting Off the Catastrophe
Reading
If the end is nigh, why aren’t we managing to take global warming seriously?
Common Dreams
Vivre le Rhône
Arpentage
d’un champ à l’autre / von Feld zu Feld
A urge to do something
Reading
An interview to climate activist Myriam Roth.
Vivre le Rhône
Vivre le Rhône: part 1
Video
Meet the Rhône and Natural Contract Lab
Vivre le Rhône
Common Dreams Panarea: Flotation School
Video
The video of the project Common Dreams Panarea: Flotation School.
Common Dreams
GLOSSARY OF TRANSITION (T — T) by Ritó Natálio
Reading
A collective, ecotransfeminist speculative fiction.
Peau Pierre
Cruel optimism
“A relation of cruel optimism exists when something you desire is actually an obstacle to your flourishing. It might involve food, or a kind of love; it might be a fantasy of the good life, or a political project. It might rest on something simpler, too, like a new habit that promises to induce in you an improved way of being. These kinds of optimistic relation are not inherently cruel. They become cruel only when the object that draws your attachment actively impedes the aim that brought you to it initially.”
These are the opening words of Cruel Optimism, a book by theorist Lauren Berlant that, in recent years, has become a key reference for anyone thinking seriously about affect, desire and precarity.
Who hasn’t, at least once, believed that working harder than necessary would help us get ahead? Or that a toxic relationship was better than being alone? Or that political commitment, on its own, could truly change things? All these promises eventually start to creak. And behind that creaking, Berlant identifies a deeper, more pervasive feeling that runs through many contemporary lives: the impasse – a condition in which we keep moving forward without really knowing where we’re going, where we’re surviving more than living, where change is both longed for, feared and always somehow postponed.

Drawing: Anaëlle Clot.
But Berlant doesn’t stop at diagnosis. They invite us to pay attention to the micro-tactics through which people try to survive within the impasse. They call these forms “self-interruption”: tiny gestures like eating erratically, compulsively scrolling, binge-watching endless series, procrastinating – things we often regard as bad habits or self-sabotage. Yet in Berlant’s reading, these are also reprieves, pauses in the relentless push for productivity, fleeting moments where the self finds shelter; acts that, while they may not change the world, express a desire to keep going and in that very persistence, carry a quiet political force.
To live in an exhausting world and somehow manage – even just for today – not to fall apart, is already a form of resistance.
Perhaps, then, we might learn something from this stance: to be gentler with ourselves, to allow space for rest, for emptiness, for pause. To accept doing nothing, from time to time, can be an act of care. And it is also a way of desiring a more liveable world.
The Nest
Here is an excerpt from The Poetics of Space by 20th-century French philosopher Gaston Bachelard. In this work, Bachelard explores spaces of human intimacy – houses, drawers, nooks, nests – not as physical objects, but as places imbued with life and imagination. The passage featured is a poetic and thoughtful meditation on the nest, viewed as a vital refuge, the centre of a universe that is both real and imagined.
It is the living nest, however, that might introduce a phenomenology of the real nest, the nest found in nature, which becomes, for a fleeting moment (and the word is not too grand), the centre of a universe, the marker of a cosmic situation. I gently lift a branch, the bird is there, brooding on its eggs. It does not fly away. It only trembles, slightly. I tremble at making it tremble. I fear that the nesting bird knows I am a man, that being who has lost the trust of birds. I remain still. Slowly – so I imagine – the bird’s fear and my fear of causing fear subside. I breathe more easily. I let the branch fall back. I’ll return tomorrow. But today, I carry a quiet joy: the birds have built a nest in my garden.
And the next day, when I return, walking even more softly, I see, at the bottom of the nest, eight eggs of a pale pinkish white. My God! How small they are! How tiny a hedge bird’s egg is!
There is the living nest, the inhabited nest. The nest is the bird’s home. I’ve long known this, it’s long been said to me. It’s such an old truth that I hesitate to repeat it, even to myself. And yet I have just relived it. I recall, with a clear and simple memory, those rare moments in life when I have discovered a living nest. How few and precious are such true memories in a lifetime!
I now fully understand Toussenel’s words:
“The memory of the first bird’s nest I found on my own has remained more deeply etched in my mind than that of the first Latin prize I won at school. It was a lovely greenfinch’s nest with four grey-pink eggs, traced with red lines like a symbolic map. I was struck on the spot by an unspeakable joy that rooted me there for over an hour. It was my calling that chance revealed to me that day.”
What a beautiful passage for those of us seeking the sources of our earliest fascinations! When we resonate, even from afar, with such a shock, we better understand how Toussenel could integrate, in both life and work, the harmonic philosophy of Fourier, adding to the bird’s life an emblematic dimension, a universe of meaning.
And even in ordinary life, for someone who lives among woods and fields, the discovery of a nest is always a fresh emotion. Fernand Lequenne, the plant lover, walking with his wife Mathilde, spots a warbler’s nest in a blackthorn bush:
“Mathilde kneels down, reaches out a finger, brushes the fine moss, holds her hand there, suspended…
Suddenly, I shudder.
I’ve just discovered the feminine meaning of the nest, perched in the fork of two branches. The bush takes on such human significance that I cry:
– Don’t touch it, whatever you do, don’t touch it!”

Drawing: Anaëlle Clot.
Toussenel’s shock, Lequenne’s shudder, both carry the unmistakable mark of sincerity. We echo them in our reading, since it is often in books that we experience the thrill of “discovering a nest.” Let us then continue our search for nests in literature.
Here is an example where a writer intensifies the nest’s role as home. We have borrowed it from Henry David Thoreau. In his writing, the entire tree becomes, for the bird, the vestibule of its nest. Already, the tree that shelters a nest partakes in the mystery of the nest. For the bird, the tree is a refuge.
Thoreau shows us the woodpecker making a home of the whole tree. He compares this act of possession to the joyful return of a family moving back into a long-abandoned house: “Just as when a neighbouring family, after a long absence, returns to their empty home, I hear the joyful sounds of voices, the laughter of children, and see smoke rising from the kitchen. The doors are flung wide open. The children race through the hall, shouting. So too, the woodpecker darts through the maze of branches, drills a window here, bursts out chattering, dives elsewhere, ventilates the home. It calls out from top to bottom, prepares its dwelling… and claims it.”
Thoreau gives us, all at once, the nest and the house unfolding. Isn’t it striking how his text breathes in both directions of the metaphor: the joyful house becomes a vibrant nest – and the woodpecker’s trust, hidden in its tree-nest, becomes the confident claiming of a home.
Here, we go beyond mere comparison or allegory. The “proprietor” woodpecker, appearing at the tree’s window, singing from its balcony, a critical mind might call this an “exaggeration.” But the poetic soul will be grateful to Thoreau for expanding the image, giving us a nest that reaches the size of a tree.
A tree becomes a nest the moment a great dreamer hides in its branches. In Memoirs from Beyond the Grave, Chateaubriand shares such a memory: “I had built myself a perch, like a nest, in one of those willows: there, suspended between earth and sky, I would spend hours with the warblers.”
Indeed, when a tree in the garden becomes home to a bird, it becomes dearer to us. However hidden, however silent the green-clad woodpecker may be among the leaves, it becomes familiar. The woodpecker is no quiet tenant. And it’s not when it sings that we think of it, but when it works. All along the tree trunk, its beak strikes the wood with resonant blows. It often vanishes, but its sound remains. It’s a labourer of the garden.
And so, the woodpecker has entered my sound-world. I’ve turned it into a comforting image. When a neighbour in my Paris flat hammers nails into the wall late into the evening, I “naturalise” the noise. True to my method of making peace with anything that disturbs me, I imagine myself back in my house in Dijon, and I say to myself: “That’s just my woodpecker, working away in my acacia tree.”
Everything Flows
As part of Faire commun – a shared ecology project in Parc Rigot – least invites you to reflect on the rhythms that flow through living beings, places and time itself. “Faire commun” also means “making time together”: exploring how our lives align – or fall out of step – with the cycles that surround us. This text invites readers to attune to the world’s many pulses, imagining new forms of sensitive coexistence.
At Parc Rigot, students, researchers and artists came together to resonate with the land – an interdisciplinary and sensory exploration aimed at revealing the unique rhythms of the landscape, its lifeforms and its uses. By observing the park’s centuries-old oaks, its passers-by and its pond, they highlighted how each element vibrates at its own tempo – sometimes steady, sometimes chaotic – composing a shared, living score.
The word “rhythm” comes from the Greek verb rhéô, meaning “to flow”. In Greek philosophy, panta rhei (“everything flows”) captures the thought of Heraclitus of Ephesus, philosopher of perpetual change: all is in constant transformation, like a river whose waters move constantly, so much so that “one can never step into the same water twice” …
Water, indeed, is at the heart of our first experience of rhythm. Even before birth, we perceive sound through amniotic fluid: heartbeats, breath, blood flow. Only low, rhythmic sounds travel through this liquid medium. After birth, part of this water remains in us: the inner ear, still filled with fluid, senses the world’s vibrations. This original water holds a deep memory of rhythm and time within us. Perhaps that is why Rigot’s pond, nestled at the base of the park, acts as a sensory magnet: it draws the eye, attracts wildlife and becomes a focal point where human and non-human rhythms converge across the day.
Humanity has long sought to measure time. One of the earliest known instruments is a water clock (clepsydra) from the 14th century BCE, discovered in the Karnak Temple in Egypt. Two vessels, connected by a small opening, allowed time’s flow to be measured steadily. At Rigot, the oaks planted on the western side play a similar role: silent timekeepers, inscribing memory into their bark year after year.
In soundscapes little touched by human activity, most sounds follow predictable rhythms. Birdsong, the rustle of wind in leaves, the soft lapping of water – these recurring motifs are registered by living beings as familiar and non-threatening. Such regularity soothes and stabilises the soul. In contrast, abrupt noises – construction, crowds, traffic – disrupt sensory balance, triggering alarm. Auditory rhythm is thus a key element of perceptual stability.
Rhythm is essential to how every species hears. Neurons in the ear and brain activate only when sound frequencies align with a reference rhythm. In the 1960s, Hungarian researcher Péter Szőke slowed down birdsong to reveal its hidden complexity, unheard by the human ear. This attention to the invisible and the subtle informs the sensory work carried out in Parc Rigot: to listen, to slow down, to observe what often slips beneath the surface of perception.

Drawing: ©Anaëlle Clot.
For living beings, time unfolds on three levels: internal rhythm, synchronisation with environmental cycles and coordination with others. Internal rhythm is fine-tuned by external signals – zeitgebers (“time-givers”) – such as light, temperature and seasons. For migratory birds, the memory of thawing snow, the length of day and the behaviour of other species help determine when to depart for breeding grounds.
Time, then, is not solely personal, it is also social. In a beehive, nurse bees maintain a constant internal rhythm, while foragers adjust to the timing of flower openings. The coordination of these internal clocks generates a shared rhythm, or a collective time.
Human societies, too, maintain diverse and complex relationships with time. In many Indigenous cultures, time is tied to local rhythms of land, animals and landscapes. Among Sámi reindeer herders, for instance, the concept of jahkodat holds that each year is unique: migration depends on the snow thawing, pasture health and other shifting factors. “One year is not the sister of the next”, a Sámi proverb says: each cycle demands careful attention and constant adaptation.
Today, globalisation has dulled this seasonal sensitivity. Yet seasonality is not universal. Some regions know four seasons; others alternate between wet and dry. In Nagori, Ryoko Sekiguchi notes that Japan traditionally divides the year into 24 seasons, or even 72 micro-seasons. This refined sense of time shapes language itself, with words and haikus linked to precise moments, weaving culture, climate and expression together.
But so-called “objective” time is also a human invention. In Austerlitz, W.G. Sebald reminds us that while time is tied to the stars, it ultimately rests on convention. Even the solar day varies; to stabilise our clocks, we invented a “mean sun” – a fictional body whose steady motion serves as a reference.
The standardisation of time intensified in the 19th century with the advent of railways. To coordinate schedules, time zones were imposed, overriding the diversity of local times. The world entered an era of strict synchronisation, a standardisation that now coexists with the ecological and temporal dissonance we face.
For non-humans, life depends on a fine attunement between living rhythms and Earth’s cycles. Climate change is unsettling these balances. At Rigot, as elsewhere, seasons shift, temperatures rise, blooms and migrations fall out of sync, disrupting biological clocks. This breakdown threatens the reproduction, food sources and survival of many species. When life’s rhythms fall out of step with Earth’s cycles, the very balance of life begins to waver.
In the face of growing dissonance between human time and living time, Faire commun calls for a sensitive reorientation: to slow down, to listen, to live together. Parc Rigot becomes a shared learning ground, where we can explore new ways of inhabiting time, neither linear or productivist, but rather cyclical, porous, attuned to what grows, changes or disappears. By reconciling Earth’s many temporalities, this project sketches the outline of an inhabitable future.
Walking in Taranto
This text was written by the artist Martin Reinartz as part of least’s research residency program in Southern Europe. This program aims to create dialogue between artists, researchers, and communities around ecological and social issues, through periods of immersion in territories strongly affected by the consequences of the environmental crisis. Martin Reinartz’s residency in Taranto, made possible thanks to our ongoing collaboration with the local collective Post Disaster, is part of this approach.
November 2024.
I’m going to Taranto as a guest artist with the Post Disaster collective of architects and urban planners. I know nothing about the city other than the stories I’ve heard about it. I don’t want to know anything more, I don’t want to pre-empt anything.
People might think that it’s unjustifiable, someone coming without a plan. I reassure myself. My plan is this total absence of a plan. I simply want to ask them, those who will welcome me, that we walk together in their city. Just two at a time. That they take me to places that are important to them, that they love. No matter whether it’s the laundromat or a friend’s house for a drink.
For me, walking is a way of getting to know a city. There’s nothing apparently productive in that act. Nothing that distinguishes me from the rest of the world, nothing that says: “this person is an artist”. No particular technique to show off, no great skill.
I try to slip into everyday life. To slip into the city and let myself be carried along by its ebb and flow. I’m not trying to produce an object. Just to be there, to experience the place and what it has to offer.
Does that mean it’s all pretence?
Can one just come along without justification? At what point does the size of a project incorporate the idea of profitability? How does this profitability influence collaborative relationships, between associate artists, between artists and organisations? I try to spot these signals. I try to be cunning. Like someone trying to get off a well-trodden road.
Peppe Frisino
“Are we meeting tomorrow in the morning? I’ll be in the old town at 8.30am and I could take you with me to some meetings. We can meet at Falanto, the bar on Via Duomo! They’re my friends, but they’re not always nice…”
Peppe Frisino is an urban planner. He’s the only member of the collective still living in the city. He lives with his family in the old town of Taranto.
It’s nine o’clock and he’s taking me to a friend’s house, a man with a shaved head in a tracksuit. Peppe introduces me as his partner. I’ve only known him for five minutes.
We go upstairs to a flat with white tiles on the floor and walls. The sofa is white, the table is light wood. Apart from that, there’s nothing in this living room.
The man explains to Peppe that he has to help him assemble a wooden frame. A huge frame measuring one metre by sixty centimetres, to which will be stapled a photo of his son, taken on the day of his communion.
Peppe, I’ll understand later, has a special role in this neighbourhood.
The old town of Taranto is built on a small island. It’s known as the historic centre because, despite its current appearance, it was and remains one of the city’s most important centres.
Everyone in the neighbourhood knows Peppe. This is his playground. He tells me that he spends 90% of his time there, while others never set foot there. Too dirty. Too run-down. Too dangerous.
Peppe walks fast. He has a cargo bike to pick up his children from school, off the island. Like you shouldn’t get away for too long.
As he crosses Via Duomo, in the heart of the island, Peppe takes his time. People stop him, he asks for news, cracks jokes, introduces me, they smile at me and speak to me in Italian.
I wonder what exactly he does for a living. What defines him. It’s impossible to understand what it means to him to be an urban planner, but I have a feeling that his approach is deeply linked to the way he relates to this place. To every person who fills the streets.
“Wednesday. Peppe is something of a trickster. Elusive, he crosses the old town of Taranto with disconcerting ease. He’s an urban planner, of course, but that title isn’t enough. He’s a neighbour, an accomplice. I’ve just arrived, and he introduces me as one of his own, blurring identities and roles. He navigates between residents, slipping from one conversation to the next, going here and there. For him, relationships take precedence over his function. Like a trickster, he doesn’t conform to expectations. He plays, improvises, twists and turns. By helping a man assemble a frame for a communion photo or chatting on the side of Via Duomo, he shapes the place without claiming it. He’s one of those figures who exist not so much by what they do as by the way they inhabit the world.”

Drawing: ©Anaëlle Clot.
Gabriella Mastrangelo
Gabriella lives in Massafra, on the outskirts of Taranto. I will join her by bus on Friday morning so she can take me to places she hasn’t told me about. I don’t seek to know. My proposal to undertake personal walks is thus taking shape. I find it reassuring.
Gabriele Leo
Gabriele came to pick me up in the historic center, by car. He explains that he arrived early that morning from Venice, where he is developing a doctoral thesis. His thesis topic: the emergence of imaginaries stemming from environmental catastrophe. His involvement in the Post Disaster collective is at the heart of his reflection.
“Post Disaster is the name of the association. It comes from Timothy Morton, an American theorist of Dark Ecology. He develops the idea that in dominant discourses, there’s much talk about the impending catastrophe, whereas in places like Taranto, the catastrophe is already here. We live in the forthcoming catastrophe, in the Post Disaster.”
Gabriele wants to take me to Mottola, a town on the outskirts of Taranto where he partially grew up. He says he’s not attached to Taranto, not like Peppe. He says he has a more complex relationship with this city, one of attraction-repulsion. “I didn’t choose to live here. I’ve rarely chosen my places of residence. Today, in Venice, I feel good.”
In Mottola, we climb one of the main streets, deserted, and arrive at a viewpoint offering one of the highest views in the region. In front of us, a few dozen kilometers away, Ilva and other factories.
Today, the pollution cloud above the factories isn’t very discernible. It varies greatly, depending on weather conditions.
People don’t come here. They don’t look at Taranto. They look at Bari. They look at Lecce. Taranto, they turn their backs on it.
“There are cities that become the reflection of a country, of its transformations, of its unresolved knots, of its failures, of its falls, but also of its aspirations for redemption. Taranto is one of those cities: a unique urban laboratory, caught between the chimneys of Ilva and the sea stretching out before its palaces, emblematic of 20th-century industrial development and its drift into a deep crisis.
Taranto is a city of layers. A city where historical, temporal, and sociological plans intertwine, often obscuring each other. Its past as the capital of Magna Graecia, a Mediterranean port traversed by cultural intermingling and foreign dominations, is just one of those layers. It’s a layer increasingly difficult to grasp, engulfed in the meanders of History and often brought to the surface in the form of dreams or hidden impulses. But the city we know today, stretching like a grayish concrete tongue over several kilometers at the top of the gulf bearing its name, is fundamentally a creation of the 20th century, marked by large industry and the development policies that shaped it.
Towards the end of the 19th century, just after Italian unification, Taranto had just over thirty thousand inhabitants, residing mainly on the ancient island constituting the old city. The construction of the military Arsenal marked the beginning of chaotic economic and urban development that would characterize Taranto throughout the 20th century. On the ruins of this military-industrial complex, the steelmaking dream was then built, the new state industry that made Taranto the most working-class city in the Mezzogiorno. But it was only much later that the extent of the damage left by this Promethean forge implanted on the shores of the Ionian Sea could be measured.” (Alessandro Leogrande, Fumo sulla città, Fandango Libri, 2013)
The “life” of objects
The relationship between human beings and objects, between subject and matter, is traditionally considered in terms of use, or even domination. Western philosophy, with a few exceptions, has generally made a strict distinction between the human world and the world of things, attributing to the former an absolute primacy in terms of agency and intentionality. Nevertheless, in our daily experience, this separation between us and the world of objects is much more nuanced, dynamic and interactive.
From a pragmatic point of view, one need only think of the myriad of technologies that surround us, from forks to computer networks that influence our lives. On a symbolic level, objects also play a fundamental role in the construction of individual and collective identities, actively participating in the formation of cultural, emotional and social representations. From this perspective, the strict distinction between subject and object fades away, giving way to a more complex network of mutual interactions.
In this context, American theorist Jane Bennett came up with the concept of “vibrant matter”. Matter should not be considered as passive and inert, but as infused with intrinsic vitality. Objects and matter are not reduced to simple instruments subject to human will, but exercise an agency of their own, influencing humans and actively participating in the construction of the social and political world.
According to Bennett, reality must be understood as a series of “assemblages”, where living and inert matter, animals and objects, particles, ecosystems and infrastructures all contribute equally to the production of effects. In her book Vibrant Matter, she cites and analyses the major power outage that struck the North American grid in 2003, plunging millions of people into darkness – an event that shows the extent to which an entity that is supposedly devoid of agency can exert a decisive influence on humans. As she writes: “To the vital materialist, the electrical grid is better understood as a volatile mix of coal, sweat, electromagnetic fields, computer programmes, electron streams, profit motives, beat, lifestyles, nuclear fuel, plastic, fantasies of mastery, static, legislation, water, economic theory, wire, and wood – to name just some of the actants.” By analysing the chain of events that led to this blackout, Bennett highlights its emergent character, which calls into question traditional concepts of responsibility and causality, as well as the distinction between subject and object. While such an approach is obviously manifested in a large-scale event, it can be extended to our entire experience of the world.
Moreover, on a scientific level, the traditional distinctions between living and non-living matter, organic and inorganic, are tending to blur. Materials considered to be inert are proving capable of growth, self-organisation, learning and adaptation to the environment. The idea that intelligence is an exclusively human trait is now obsolete and misleading: this is the premise on which Parallel Minds by chemist and theorist Laura Tripaldi is based. In this book, she focuses in particular on the concept of interface, which we often associate with digital technologies, but which, in chemistry, refers to a three-dimensional space with mass and thickness, where two distinct substances come into contact. In this space of interaction, materials adopt unique behaviours: Tripaldi takes the example of water, which, on contact with a smooth surface, takes the form of a drop.

Drawing: ©Anaëlle Clot.
More than a technical notion, the interface invites us to rethink our relationship with matter: “In this sense, the interface is the product of a two-way relationship in which two bodies in reciprocal interaction merge to form a hybrid material that is different from its component parts. Even more significant is the fact that the interface is not an exception: it is not a behaviour of matter observed only under specific, rare conditions. On the contrary, in our experience of the materials around us, we only ever deal with the interface they construct with us. We only ever touch the surface of things, but it is a three-dimensional and dynamic surface, capable of penetrating both the object before us and the inside of our own bodies.”
The act of “touching” is also central to the thinking of philosopher and physicist Karen Barad. In her book On Touching – The Inhuman that Therefore I Am, Barad explains that, from the point of view of classical physics, touch is often described almost as an illusion: indeed, the electrons that make up the atoms of our hands and the objects we touch never actually meet but repel each other due to electromagnetic force. This means that any contact experience always occurs at a minimum distance, thus defying our sensory intuition.
Barad goes even further by analysing the question through quantum field theory, which introduces the possibility that matter is not something static and defined, but rather a continuous tangle of relationships and possibilities. The separation, which seems obvious to us, between one body and another fades away, because the boundaries between the “self” and the “other” are continually redefined, in a process that Barad calls intra/action and which would constitute the very essence of our reality – a reality where everything is constantly co-produced and co-determined. This principle implies that identity is not something pre-established but the result of infinite variations and transformations, according to a queer and non-binary model.
These approaches invite us to rethink our relationship with everyday objects and with matter in general. If matter has an agency of its own, we must recognise our belonging to a complex and interconnected system, with philosophical, political and ecological implications. Accepting that matter shapes us as much as we shape it, implies increased responsibility for our technological and environmental impact and, ultimately, for ourselves, as we inhabit assemblages, interfaces and intra/actions.
Emergency and Cocreation
Antonella Vitale is an architect who has spent part of her career designing refugee camps. Today, talking about displaced people and temporary spaces is not only a way of addressing humanitarian crises, it also implies a broader reflection about what it means to live and cohabit in a world marked by instability and climate change. The experience gained in these contexts shows that it is possible to meet basic housing needs even with limited resources, by directly involving communities and experimenting with more flexible and appropriate solutions. In refugee camps, co-creation and adaptation strategies emerge that can inspire a more general approach to architectural design. At a time of ecological emergency and forced migration, understanding how to ensure dignified living conditions in precarious situations means questioning the vulnerabilities of our own cities and rethinking the ways in which communities can be involved in the construction of living spaces.
What is the link between ecological emergency and migration?
Environmental problems, such as the scarcity of natural resources, desertification, and ecological disasters, are often closely linked to conflict and migration. The construction of refugee camps also brings its own challenges. For example, a side effect of their presence is deforestation, as displaced people need wood for cooking and, in some cases, their settlements expand. It’s important to remember that these people often live in tents for years and build temporary structures of their own accord.
How long are we talking about?
The average time spent in a camp is 17 years. That’s why humanitarian culture has evolved over time: in the past, we simply provided food, water, and temporary accommodation. Today, the aim is to offer as normal a life as possible. Rather than providing temporary accommodation, the idea is to house displaced people with local residents or in reallocated structures, if the local authorities allow it. Refugee camps do not facilitate integration because they create ghettos; they are now seen as a last resort.
What type of facilities are generally available to these populations?
Tents and containers are among the most expensive options in non-European contexts, if only for transport. Tents, in particular, are very precarious and uncomfortable, and depending on the climate, might only last six months. In addition, camps are often set up on land that hasn’t been built on, and there’s usually a good reason why: it could be prone to flooding, too hot, or impossible to cultivate. In general, it remains crucial to move as quickly as possible from the emergency response phase to a transitional phase, and then on to greater stability.
Have you had any experiences of this kind in your work?
During my assignment in Mozambique, I was involved in extending a refugee camp to accommodate an additional 5,000 people. I took over the project after the departure of my predecessor, who had encountered a number of management difficulties. One of the main problems was the fires lit by the camp residents in protest. When I arrived, the situation was complex, and the safety rules were very strict: I had to respect a time limit in the camp and return to my base before sunset. It was one of my first experiences, and I found myself faced with a major challenge, with no clear guidelines on how to proceed, and few resources.
What approach did you take?
I chose to maximise my time in the camp by starting to interact with the different communities. The camp was home to groups from the Great Lakes region of Africa, people marked by deep-rooted tribal conflict. I tried to understand their situation and involve them in the decision-making process, giving them the task of pointing out problems and essential needs. If I hadn’t done this, there would probably have been opposition, because unwittingly, for example, we would have exacerbated enmities between clans by intervening in stories we couldn’t understand, and fuelling tensions.
What strategies did you use to involve the camp residents?
The key moment was the launch of the design and planning phase. I let the residents tell me their needs, aspirations, and preferences for the layout of the homes. For me, the most important thing was to respect the number of people to be housed, while the distribution of the spaces was up to them. This approach had a very positive impact on the feasibility of the project. My constant presence in the camp also helped to deconstruct the prejudice that international aid workers are distant, locked away in their air-conditioned offices or jeeps. By showing that I was willing to listen, I fostered a climate of trust.
How did you overcome the language barrier?
To facilitate communication and mutual understanding, I chose to display the project drawings in visible places in the camp. This aroused the curiosity of the residents, who approached me for information in order to take an active part in meetings. Thanks to this method, we were able to better define the distribution of living spaces according to the real needs of the community. In the end, the key element of this experience was not the technical aspect, but the ability to listen and respond to people’s needs, initiating a process of co-creation that made the project more effective.

Drawing: © Anaëlle Clot.
How did you intervene in public spaces?
The camp included empty areas that served as natural gathering points, such as those around the water pumps, often located under large trees. One of these points was close to the therapeutic feeding centre for children under five and not far from the school. I analysed these existing synergies and integrated them into the creation of a sports field, strategically positioned to encourage physical activity and movement.
In addition, in this area I introduced a more structured communication system, using a tree as a display point for comments, suggestions, and complaints from the community. Although there was more criticism than praise, this system established a clear and direct channel of communication. My aim was to facilitate discussions between the operators and the community, gathering useful feedback to improve the management of the camp. When there’s participation, co-creation or at least an exchange of ideas, people are willing to get involved, especially if it has to do with buildings or the use of space.
How much freedom was there for self-designing buildings?
In Mozambique, we involved people in the construction of houses using local materials: reeds, earth, and straw. Each family was provided with the same quantity of materials, and they could then decide how to use them by appropriating the project. The idea was to move on from tents to very simple but permanent houses, in line with Mozambican standards. It’s also important to bear this in mind: when offering an emergency solution to a population from outside the country, you mustn’t go beyond what the most disadvantaged members of local society have, so as not to fuel tensions.
Are there other levels of co-creation that are desirable in such a context?
Before leaving their country of origin, displaced people had a trade, occupations, and passions. Mapping these skills is an asset that can be exploited to the full, firstly to integrate these people into the world of work and make them self-sufficient, and secondly to contribute to aid programmes for displaced people. Since resources are limited, taking advantage of local skills is a great opportunity. It’s not always easy, it takes time, and you have to meet people, but it’s of enormous benefit to the community, which feels respected rather than marginalised.
Are there any spontaneous practices in the public space that help to foster cohesion?
Food is an important tool of cultural identity, especially in contexts of great disorientation. The opportunity to grow traditional foods not only provides a means of subsistence but also enables people to maintain a link with their culture of origin and share it with the local population. This practice creates opportunities for cultural exchange, for example through small food outlets where camp residents can share their cuisine. It can also facilitate the exchange of agricultural or culinary techniques useful to both the refugee and host communities.
What is the relationship between emergency and planning?
Emergency and planning are almost antagonistic, because in an emergency situation, by definition, there is no time or opportunity to plan. However, we mustn’t fall into the trap of continuous emergency either, as that would be naïve, costly, and politically dangerous. In an emergency, many rules have to be waived. Legislation requires time, strict processes, and co-creation, but it is also the only way forward.
What can we learn from housing in emergency contexts?
In emergency contexts, we learn that delaying action progressively reduces the options available, until none are left. Today’s multiple crises, including climate change, teach us that it is essential to act in time, even in Europe, where, despite resources, cities are not ready to face current and future environmental challenges.
In some parts of the world, climate crisis is gradually rendering entire regions uninhabitable. The problem is not just rising temperatures, but the disappearance of vital resources, forcing people to migrate. However, global attention is more often focused on protecting against migratory flows than on long-term interventions to prevent crises.
Living Soil
Although we walk on it every day and it is essential to our food security, we rarely consider the importance of soil in our lives. What crucial roles does soil play in maintaining the balance of ecosystems? How can we protect it? And how can artistic practices help?
Below is an interview with Karine Gondret, a trained soil scientist and geomatician, HES-SO research associate and lecturer at the Geneva School of Landscape, Engineering and Architecture (HEPIA). Her research focuses on soil quality assessment and mapping.
What is pedology?
A branch of soil science, pedology focuses on the study of soils, i.e. the interactions between living organisms, minerals, water, and air that take place beneath our feet. In pedology, we examine everything that lies between the surface and the first, purely mineral layer, i.e. around 1.50 m deep in our latitudes. Beyond that, when only minerals remain, we enter the field of geology. The role of the pedologist is also to map the soil.
What is meant by good quality soil?
Broadly speaking, good quality soil is soil that is capable of performing the functions necessary for the survival of all living organisms and their environment. Several functions are very important, beyond the most obvious, that of food or biomass production. Soil infiltrates, purifies, and stores water, and recycles nutrients and organic matter. There is also the genetic reserve function, which is still seldom studied. Penicillin, for example, was discovered in the soil. So it’s crucial to protect our soils.
What parameters need to be taken into account to assess the quality of a soil according to its functions?
In general, the higher the organic content of soil, the better it is able to perform its functions. By organic, we mean all living things (earthworms, micro-organisms, bacteria, etc.) and all carbon-rich compounds derived from living things (corpses, excrement, roots, dead leaves, compost, root and bacterial exudates, etc.). Functioning soil is living soil, and much more!
There are several other essential parameters, such as soil depth, pH, texture, porosity, etc. Depending on the function, certain parameters will be more or less important. For example, the function of supporting human infrastructure (roads, buildings, etc.) will inevitably be detrimental to the biomass production function. That’s why politicians have to make choices about the functions they want to protect.
Why is the presence of organic matter in soils important?
Organic matter is the basic food source for the soil’s fauna and micro-organisms. It is continually broken down by soil life into nutrients that are accessible to plants via soil water. Organic matter also improves soil porosity. Porosity is essential for the proper development of life, as it allows nutrient-rich water, air, and roots to circulate. Without this porosity, exchanges are much less effective, and as a result, its functions are much less effective.
In addition, organic matter is capable of increasing the soil’s capacity to store water and of mitigating flooding in towns downstream. It can also retain nutrients and pollutants through its electrical properties. Finally, organic matter that is stabilised in the soil contains around 60% of carbon, and the more it increases in the soil, the more we limit global warming, because all the carbon that is not stored in the soil goes into the atmosphere in the form of CO2.
We’ve talked about what good soil is for humans, but what about the “more than human” world?
As defined by the Food and Agriculture Organisation (FAO), soil performs functions that are essential to humankind. In truth, these functions are essential to the proper functioning of ecosystems, and humans simply benefit from them. For example, many pollinators spend part of their life cycle in the soil. These pollinators make it possible to obtain fruit and feed wildlife, which is beneficial for natural environments. But this fruit also benefits humans within agricultural and economic infrastructures, when it is sold. Humans and the environment are deeply interconnected, although we tend to forget this. Finally, compared to about fifty years ago, the organic matter content in most agricultural soils has halved. This means that these soils are becoming increasingly less effective at performing the functions they provide for us.
Images: Thierry Boutonnier, Comm’un sol, 2024. Photo: ©Eva Habasque.
As part of the Faire Commun research project, artist Thierry Boutonnier devised a method for sensitively assessing the quality of the soil in Parc Rigot. He organised a picnic on a long organic cotton tablecloth, which was then cut into pieces and buried in different areas of the park. After a few months, the tablecloth was dug up, and the amount of fabric consumed thanks to the soil’s bioactivity provided concrete information about its characteristics. What did you observe?
We haven’t yet finished carrying out the analyses in Parc Rigot, but we’ve observed the soil’s capacity to degrade organic matter through this experiment. In the soil, micro-organisms release enzymes that degrade organic matter (here the cotton tablecloth). We also observed that these micro-organisms were not all equally active: in some areas of the park, the organic matter was broken down very efficiently, while in other areas, the process was much slower. This means that in these areas, there are fewer nutrients available for the plants that grow.
People often don’t realise that there is diversity of soils, even in small areas. In the city, as in Parc Rigot, this diversity is even more marked because humans have had such a strong impact on the soil. There have been many interventions – areas have been completely renatured, others stripped, or artificially added – and this has led to a juxtaposition of very different soils. The challenge is to identify the areas that really work, and protect them.
Is it possible to improve soil quality?
When soil doesn’t have the necessary quality for a given function, we can intervene to improve it, for example by adding organic matter or by decompacting it (in compliance with the OSol ordinance in Switzerland). Nevertheless, soil quality only improves very slowly; sometimes it takes several human generations, sometimes improvement is impossible. Soil is a non-renewable resource, as it takes a very long time to create: it is said to increase by an average of 0.05 millimetres per year. In very steep areas, it even becomes thinner and thinner.
It can also deteriorate rapidly. It looks solid and is thought to be immutable, but nothing could be further from the truth. Even when we’re trying to improve its quality, we have to be very careful, because every intervention on the soil leads to its deterioration. It’s a delicate process that doesn’t always work – we’re still experimenting.
Soil is at the intersection of physics, biology, and chemistry. It’s a complex world, and by no means do we know everything about it. So it’s all the more important to protect it, because it’s where all plant nutrients are found, and as they develop, they form the basis of the diet of all mammals. The soil is truly the place where life is created.
Fences and Power
“We pray your grace that no lord of no manor shall common upon the common.
We pray that all freeholders and copyholders may take the profits of all commons, and there to common, and the lords not to common nor take profits of the same.
We pray that Rivers may be free and common to all men for fishing and passage.
We pray that it be not lawful to the lords of any manor to purchase lands freely, (i.e. that are freehold), and to let them out again by copy or court roll to their great advancement, and to the undoing of your poor subjects.”
The date is 6 July 1549. The peasants of Wymondham, a small town in Norfolk, England, have risen in rebellion. They are marching across the fields to cut down the hedges and fences of private farms and pastures, including the estate of Robert Kett, who surprisingly joins the protests, giving his name to the rebellion. As they march, they are joined by farm workers and craftspeople from many other towns and villages. On 12 July, 16,000 insurgents camp at Mousehold Heath, near Norwich, and draw up a list of demands addressed to the King, including those mentioned above. They will hold out until the end of August, when more than 3,500 insurgents will be massacred and their leaders tortured and beheaded. But what provoked this insurrection? And why was the repression so bloody?
Kett’s Rebellion was a reaction to the hardships inflicted by the extensive enclosures of common lands. These lands, which were of great economic and social importance, were managed according to rules and boundaries established by the communities themselves, guaranteeing a balance between their members. The plots were used for grazing, gathering wood and wild plants, haymaking, fishing, or simple passage, and even included shared farmland, where peasants each cultivated small portions of the collective land. The common land system thus contributed to the subsistence of the communities and, in particular, the most disadvantaged.
With enclosures, common land was reorganised to create large, unified fields, demarcated by hedges, walls, or enclosures, and reserved for the exclusive use of large landowners or their tenants. This gradual process of land appropriation was not exclusive to England but was a large-scale phenomenon that spread in various forms throughout Europe (and even more violently in its colonies) from the 15th century onwards. This is the phenomenon that Karl Marx describes in Das Capital as “primitive accumulation”: agricultural workers, deprived of their means of production (land), are forced to work for wages, possessing nothing other than their labour power. This was one of the factors that led to the emergence of capitalism, a process involving violence, expropriation, and the breaking of traditional social ties.

Drawing: ©Anaëlle Clot.
Another significant aspect of enclosures is their impact on the role of women. Until the Middle Ages, a subsistence economy prevailed in Europe, in which productive work (such as tilling the fields) and reproductive work (such as caring for the family) had equal value. With the transition to a market economy, only work that produced goods was considered worthy of remuneration, while the reproduction of labour power was deemed to have no economic value. What’s more, as we have shown, the loss of use rights over common land particularly affected already-discriminated groups such as women, who found in this land not only a means of subsistence, but also a space for relationships, knowledge sharing, and collective practices.
Feminist researcher Silvia Federici, in her celebrated book Caliban and the Witch: Women, the Body and Primitive Accumulation, reflects on the link between the privatisation of land and the worsening of women’s condition: “For in pre-capitalist Europe, women’s subordination to men had been tempered by the fact that they had access to the commons and other communal assets (…). But in the new organisation of work every woman (…) became a communal good, for once women’s activities were defined as non-work, women’s labour began to appear as a natural resource, available to all, no less than the air we breathe or the water we drink (…). According to this new social-sexual contract, proletarian women became for male workers the substitute for the land lost to the enclosures, their most basic means of reproduction, and a communal good anyone could appropriate and use at will.”
The consequences of this exacerbation of power relations between the sexes were manifold: women found themselves increasingly confined to the domestic sphere, economically and socially dependent on male authority, and controlled in the management of their bodies by demographic policies that were essential to a society dependent on the flow of labour power. Control of the female body, through the condemnation of contraception and the traditional knowledge associated with care, became central to the emerging capitalist society. The witch-hunts that struck down thousands of women in Europe and America were part of this repression and control.
In the European colonies, similar processes of expropriation and violence were justified by the rhetoric of domination over “savages”. This pattern, based on the extraction of resources and cheap labour, continues to this day: think of the appropriation of indigenous lands in the global South for the exploitation of natural resources. Capitalism and oppression are two sides of the same coin.
Jean-Jacques Rousseau, in his Discourse on the Origin and Basis of Inequality, wrote: “The first person who, having enclosed a piece of ground, bethought himself of saying This is mine, and found people simple enough to believe him, was the real founder of society. From how many crimes, wars and murders, from how many horrors and misfortunes might not any one have saved mankind, by pulling up the stakes, or filling up the ditch, and crying to his fellows, ‘Beware of listening to this impostor; you are undone if you once forget that the fruits of the earth belong to us all, and the earth itself to nobody.’”
Rousseau’s thinking in this book is not without its problems, and, among other things, fuelled the dangerous myth of the “good savage”, which would in part justify colonialism. Yet these words represent a warning and a hope, inviting us to question the very foundations of society: structures, institutions, and economic systems are not immutable. Change is always possible, provided we have the courage to imagine it.
Autumn in the Garden
The gardener, hands immersed in the soil and in constant contact with plants, might seem to have an idyllic job in the face of urban hassles. But, according to Karel Čapek, nothing could be further from the truth. In his book The Gardener’s Year (1929), Čapek describes the gardener’s problems and tribulations in the face of frost, drought, and the overweening ambitions of small urban gardens. His wonderfully written tale, imbued with irony, offers a reflection on the complexity of human nature, not without a touch of humour and levity. Below is a short extract from the book.
We say that spring is the time for germination; really the time for germination is autumn. While we only look at nature it is fairly true to say that autumn is the end of the year; but still more true it is that autumn is the beginning of the year. It is a popular opinion that in autumn leaves fall off, and I really cannot deny it; I assert only that in a certain deeper sense autumn is the time when in fact the leaves bud. Leaves wither because winter begins; but they also wither because spring is already beginning, because new buds are being made, as tiny as percussion caps out of which the spring will crack. It is an optical illusion that trees and bushes are naked in autumn; they are, in fact, sprinkled over with everything that will unpack and unroll in spring. It is only an optical illusion that my flowers die in autumn-; for in reality they are born. We say that nature rests, yet she is working like mad. She has only shut up shop and pulled the shutters down; but behind them she is unpacking new goods, and the shelves are becoming so full that they bend under the load. This is the real spring; what is not done now will not be done in April. The future is not in front of us, for it is here already in the shape of a germ; already it is with us; and what is not with us will not be even in the future. We don’t see germs because they are under the earth; we don’t know the future because it is within us. Sometimes we seem to smell of decay, encumbered by the faded remains of the past; but if only we could see how many fat and white shoots are pushing forward in the old tilled soil, which is called the present day; how many seeds germinate in secret; how many old plants draw themselves together and concentrate into a living bud, which one day will burst into flowering life—if we could only see that secret swarming of the future within us, we should say that our melancholy and distrust is silly and absurd, and that the best thing of all is to be a living man—that is, a man who grows.
Image: Natália Trejbalová, Few Thoughts on Floating Spores (detail), 2023.
Courtesy of the artist and Šopa Gallery, Košice. Photo: Tibor Czitó.

How happy is the little stone
In this brief poetic composition, Emily Dickinson celebrates the happiness of a simple, independent life, represented by a small stone wandering freely. Far from human worries and ambitions, the stone finds contentment in its elemental existence. Written in the 19th century, the poem reflects the growing disillusionment with industrialisation and urbanisation, which led many to aspire to a more modest and meaningful life.
How happy is the little stone
That rambles in the road alone,
And doesn’t care about careers,
And exigencies never fears;
Whose coat of elemental brown
A passing universe put on;
And independent as the sun,
Associates or glows alone,
Fulfilling absolute decree
In casual simplicity

Image: Altalena.
Ô noble Green
O noble Green, rooted in the sun
and shining in clear serenity,
in the round of a rotating wheel
which cannot contain all the earth’s magnificence,
you Green, you are wrapped in love,
embraced by the power of celestial secrets.
You blush like the light of dawn
you burn like the embers of the sun,
O most noble Viriditas.
This magnificent hymn to the creative power of “green” is a responsory written and set to music by one of the most brilliant minds of medieval Europe: Hildegard of Bingen, a Christian saint and mystic who lived in the Rhineland in the early 12th century. The tenth daughter of a noble family, from an early age Hildegard was subject to visions and migraines, and for this reason she was destined for the convent already at the age of thirteen. She would only confess and publicly describe her visions at the age of forty-three, prompted by a divine order; a few years later, she founded the monastery of Bingen, of which she was abbess.
Hildegard’s merits are countless: she is the first Western female composer of whom we have written testimony, and her body of music is the most substantial of the era in which she lived to have come down to us. She was an excellent naturalist: her mighty treatise Physica includes 230 chapters on plants, 63 chapters on elements, 63 chapters on trees, and many more on stones, fish, birds, reptiles, and metals, enriched with indications of their medicinal properties: for this reason, some consider her the founder of naturopathy. Her homilies and speeches, imbued with a form of revolutionary vitalism that was unknown to the ecclesiastical thinking of the time, were encouraged and even published with the support of powerful popes and prelates such as Bernard of Clairvaux – a truly exceptional fact in the profoundly misogynistic context of medieval Europe.
Hildegard, however, encountered some difficulty in describing her visions: “In my visions, I was not taught to write like the philosophers. Moreover, the words I see and hear in my visions are not like the words of human language but are like a burning flame or a cloud moving through the clear air.” How do you convey something that cannot be spoken? How do you give voice to new concepts, unknown to the theologians and wise men of the time? How do you criticise the very structure of current thought? Hildegard did not choose the easy way, but decided to invent a new language, which she called Ignota Lingua and which is considered one of the first “artificial languages” ever created (Hildegard is in fact considered the patron saint of Esperanto). Her “dictionary” is actually a glossary of 1011 words, mostly transcribed into Latin and medieval German with the help of a scribe.

Image: Hildegard of Bingen, The hierarchy of angels, sixth vision of the Scivias manuscript.
Among many wonderful linguistic inventions, the concept of viriditas recurs in her writings. Scholar Sarah L. Higley attempts a translation: “viriditas, ‘greenness’ or ‘greening power’, or even ‘vitality’, is associated with all that partakes of God’s living presence, including blossoming nature, the very sap (sudor, ‘sweat’) that fills out leaves and shoots. It is (…) closely associated with humiditas, moisture. Hildegard writes (…) that ‘the grace of God glitters like the sun and sends forth its gifts variously: one way in wisdom (sapientia), another in viridity (uiriditate), a third in moisture (humiditate). In her letter to Tenxwind she compares the virginal beauty of woman to the earth, which exudes (sudat) the greenness or vitality of the grass. The Virgin Mary, of course, is viridissima virga, the ‘greenest branch,’ in Hildegard’s Symphonia. Aridity, on the other hand, represents incredulity, a lack of spirituality, the abandonment of the virtues in their greenness: that which withers and is consumed at the moment of Judgement.
For the inner eye of the mystical naturalist, capable of scrutinising the invisible in the visible, the whole of creation is a flow of divine, gushing green sap. Hildegard attached great importance to the colour green, a symbol of vigour, youth, creative power, efflorescence, fructification, fertilisation, and regeneration. Celebrating greenness for Hildegard is recognising that we are part of a whole, without separation, and serves to maintain the cohesion between soul and body. This radical thinking requires new words, new ways of thinking: inventing a language is an act that helps us understand that everything can be called into question, everything can be imagined from new premises.
Below is a selection of words of the Ignota Lingua from the chapter on trees (translated to English by Sarah L. Higley): an invitation to (re)think everything, starting with the most common words.
Lamischiz — FIR
Pazimbu — MEDLAR
Schalmindibiz — ALMOND
Bauschuz — MAPLE
Hamischa — ALDER
Laizscia — LINDEN
Scoibuz — BOXWOOD
Gramzibuz — CHESTNUT
Scoica — HORNBEAM
Bumbirich — HAZEL
Zaimzabuz — QUINCE
Gruzimbuz — CHERRY
Culmendiabuz — DOGWOOD
Guskaibuz — WINTER OAK
Gigunzibuz — FIG
Bizarmol — ASH
Zamzila — BEECH
Schoimchia — SPRUCE
Scongilbuz — SPINDLE-TREE
Clamizibuz — LAUREL
Gonizla — SHRUB?
Zaschibuz — MASTIC
Schalnihilbuz — JUNIPER
Pomziaz — APPLE
Mizamabuz — MULBERRY
Burschiabuz — TAMARISK
Laschiabuz — MOUNTAIN ASH
Golinzia — PLANE TREE
Sparinichibuz — PEACH
Zirunzibuz — PEAR
Burzimibuz — PLUM
Gimeldia — PINE
Noinz — CHRIST’S THORN
Lamschiz — ELDER
Scinzibuz — SAVIN SAVINE
Kisanzibuz — COTTON TREE
Vischobuz — YEW
Gulizbaz — BIRCH
Scoiaz — WILLOW
Wagiziaz — SALLOW
Scuanibuz — MYRTLE
Schirobuz — MAPLE
Orschibuz — OAK
Muzimibuz — WALNUT
Gisgiaz — CALTROP
Zizanz — BRIAR
Izziroz — THORN TREE
Gluuiz — REED
Ausiz — HEMLOCK
Florisca — BALSAM
The Multiciplity of the Commons
Swiss philosopher Yves Citton’s areas of research range from literature to media theory and political philosophy. We met him as part of our Faire Commun project to discuss a central theme of our research: the commons. Below is a transcript of part of his talk.
I’d like to introduce the “commons” by trying to qualify a certain image – which isn’t wrong, but quite partial – of the commons as pre-existing human appropriation. According to folklore, the Earth and its goods were shared by all animals and all featherless bipeds like ourselves. Then, according to Rousseau’s second discourse, human appropriation became the source of all evils.
This means that the commons are given as they are by nature. It’s true that the air we breathe, for example, wasn’t created by humans so that they wouldn’t die of asphyxiation: on Earth there is air, and we humans benefit from it. It’s a certain layer of the commons that we enjoy naturally, even if we don’t know exactly what nature means.
We can also say that air and water are quite similar commons. On Earth, there’s salt and fresh water, which is drinkable. But if you think about the reality of water today, the water we drink is more or less natural water. We know that it can contain chlorine, that it flows through pipes. Hence, to my mind, water isn’t at all a natural commons. It’s the result of an infrastructure, which can be public, private, or associative; it can be democratic or subject to capitalism. It’s mediated by the community or public institutions. In order to distinguish between public and private commons, I’d call this case public – a government has intervened, made regulations, and financed the pipes.
It’s still a commons, but one that has been constructed by humans, legislation, and political processes. Most of the time, when we talk about the commons today, these elements are inevitably involved. Even forests no longer look like they did before humans brought domesticated species and technologies into them. So I think it’s more realistic to say that the commons include a human artificialisation and preservation dimension. We don’t necessarily need to take care of the air – it’s enough not to pollute it – but we do need to preserve water, pipes, and infrastructures.
It’s interesting to consider another, slightly different model of the commons, i.e. language. Language didn’t precede humans, there was no French language 300,000 years ago; it isn’t an institution, nor an infrastructure regulated by a state that cares for and maintains it. French resides both within and between us. To my mind, it’s the most bizarre and extraordinary model of the commons, existing only because we own it: if all the people who speak French disappeared, there’d be no more French. (That’s without taking into account books written in French, which would remain of course). Knowing where a commons lies, whether it’s artificial or public, is no easy task. For me, what language highlights about the commons is the fact that it can exist without official regulation. The Académie française did not create the French language. Language is reproduced through culture and through children talking to their parents. It’s a commons: it’s neither totally public nor totally private.

Image: Mattia Pajè, Il mondo ha superato se stesso (again), 2020
The French language, air and water are elements that are necessary to our survival, and we’re grateful that they’re available to us: we can define them as positive commons. Conversely, there are negative commons, which are a continuation and a reversal of the latter. Researchers Alexandre Monnin, Diego Landivar, and Emmanuel Bonnet use the term “negative commons” to refer to nuclear waste, to cite only the most telling example. Whether a nuclear power station has public or private status doesn’t change the fact that the resulting waste becomes a collective problem for hundreds of thousands of years to come. It’s clear that nuclear waste is a commons, just as plastic and the climate are. Indeed, the climate, like water, is becoming an element that needs to be maintained if it’s to remain liveable. Some negative commons are therefore blending in with commons that were traditionally seen as positive. These negative commons pose a major problem: they feed our lives (the nuclear power station feeds my computer, which allows me to communicate) but they harm our living environments. Feeding and harming are seen as two sides of the same coin, at the same time. Nuclear energy provides me with electricity but harms future generations through the production of radioactivity.
If we develop this idea further, we can see finance as a good example of a negative commons: finance feeds our investments and the state budget but pollutes our environments by pushing to maximise profits at the expense of environmental considerations. How do we get out of this? How can we dismantle finance? It’s even more interesting to ask whether universities are not a negative commons: knowledge is developed, and research carried out, but the way universities operate can be toxic, with some teachers taking advantage of their power over their students, for example. There’s also bureaucracy that prevents us from doing good work at the same time as framing and structuring that work. There are toxic elements that need to be dismantled, but it’s not easy because they feed us. The intellectual exercise of projecting a negative commons hypothesis onto different subjects is therefore quite revealing.
There’s also the concept of undercommons, a term defined by Afro-American poet and philosopher Fred Moten and activist and researcher Stefano Harney. This term is based on the political ideas of the Black Radical Tradition in the United States. The over-representation of black people, particularly black men, in prisons in the United States today is dramatic, and there’s a continuity between slavery a few centuries ago and racial domination in this country today. The people who emerged from the slave holds were never considered as individuals in their own right. They therefore had to develop other modes of sociality, alternatives to the individualistic socialisation of the homo economicus, the small businessman, the white bourgeois. The communities that were threatened with lynching until a few decades ago and are now victims of police violence, live in conditions of marginalisation or at least do not enjoy the privileges that you and I, as white people in Switzerland or France, have been able to enjoy. These people have therefore developed an alternative, underground form of socialisation: a somewhat paralegal or semi-legal form of solidarity, since US law is made by white people for white people. Instead of seeing this form of solidarity as illegal, it might be seen as a different form of solidarity, outside the law, but one that is worthy of consideration and study. It enables ways of living that feed the commons, even if they’re less visible. And it could prove crucial for all of us: the infrastructures that sustain our luxuries and our forms of economic and social individualisation, as we know them today, may not last indefinitely. It would therefore be in our interests to familiarise ourselves with this form of “survival solidarity”. And of course, before doing so, it’s important to denounce and fight against the persistent oppression that weighs on marginalised populations.
I had the opportunity to work with Dominique Quessada, who came up with the idea of writing the term “commun” (commons in French) as “comme-un” (literally “as one”): his idea being that the commons belongs to everyone and to no one at the same time. The very fact of talking about the commons perhaps presupposes that the term is established, that there are people who see it as a real possibility, and that behind the dissolution of identity and property, the commons is something in which everyone can participate: it’s a plural, it’s neither mine nor yours. Above all, to write it “comme-un” suggests that the unity (of a certain people, of a community) that is often thought of as inherent to the commons is perhaps no more than “acting-as-if we were one”. Faced with the commons, we act “as one”, but we remain diverse, different, and sometimes antagonistic to one another.
Behind the commons there are always two concepts. First of all, there is the principle of unity: who are those who speak of a “commons”? On what do they base themselves? In reality, they can only defend a commons because they’re already united. Secondly, the commons is always a collective fiction: calling something a “commons” means that it is considered as such and thus develops characteristics of a commons. A public park is a public park because it is declared to be one. Thanks to this label, it’s possible to do things in this park that would otherwise have been impossible. But this remains a temporary fiction: a change of regime, a sale, an occupation of the site can always happen. In short, writing “comme-un”, or “as-one”, with a hyphen means asking two questions. Firstly, what is this unity, however heterogeneous, that allows us to say that there is a commons? Secondly, what is the fictional element, the dynamic that allows us to forge a concept that doesn’t exist? The imaginary dimension of the commons always remains central to its defence.
Experiencing the Landscape
In everyday language, the term “landscape” encompasses a variety of notions: it can refer to an ecosystem, a beautiful view, or even an economic resource. However, the complexity of the term can be better understood and approached through the concept of “experience”.
Experience is something that brings us into contact with the outside, with otherness: in this context, the landscape is no longer seen as an object, but rather as a relationship between human society and the environment. An experience is also something that touches us emotionally, that moves and transforms us. Viewing a “landscape” as such helps us realise how much it gives meaning to our individual and collective lives, to the extent that its transformation or disappearance leads to the destruction of sensitive markers of existence in the lives of its inhabitants. Experience can also be seen as a form of practical knowledge or wisdom. It is the kind of knowledge that is acquired by living in a place, which makes the people who inhabit a landscape its experts. Finally, experience is also a form of experimentation: this is the active aspect of our relationship with the world, enabling us to discover and create new knowledge and to bring to life what is yet only potential.
We might take these reflections a step further and argue that human beings live off the landscape—a statement that may seem hyperbolic, but that makes sense if we pay close attention. Indeed, the landscape is the source of our food: we live in the landscape and the latter activates representations and emotions within us. Our relationship with the landscape is dynamic: by changing it, we also change ourselves. It is therefore impossible to avoid entering into a relationship with the landscape. The very choice of ignoring and not ‘experiencing’ a landscape can have practical and symbolic consequences.
It is on the basis of these observations that Jean-Marc Besse wrote La Nécessité du Paysage (the Necessity of the Landscape): an essay on ecology, architecture, and anthropology, as well as an invitation to question our modes of action. In it, the French philosopher warns us against any action on the landscape: an attitude that places us ‘outside’ the said landscape, which, as mentioned above, is simply not plausible. Acting on a landscape means fabricating it, in other words starting from a preconceived idea that ignores the fact that the landscape is a living system and not an inert object. “Acting on therefore involves a twofold dualism, separating subject and object on the one hand, and form and matter on the other.”
So how might we escape this productive yet falsifying paradigm? Besse suggests a change of perspective: moving from acting on to acting with, recognising “that matter is animated to a certain extent” and envisaging it “as a space of potential propositions and possible trajectories”. The aim, in this case, is to interact “adaptively and dynamically”, to practise transformation rather than production. Acting with means engaging in ongoing negotiation, remaining open to the indeterminacy of the process, and being in dialogue with the landscape: in a word, collaborating with it.

Georg Wilson, All Night Awake, 2023
Acting with the soil
The “abiotic” dimension of soil is addressed, among other disciplines, by topography, paedology, geology, and hydrography. However, from a philosophical point of view, soil is simply the material support on which we live. This is where we construct the buildings we live in and the roads we travel on, and it is the soil that makes agriculture possible, one of the oldest and most complex fundamental manifestations of human activity. This “banal” soil is therefore in reality the focus of a whole series of essential political, social, and economic issues, and as such it raises fundamental questions. What kind of soil, water, or air do we want? The environmental disasters linked to the climate crisis and soil erosion or the consequences of the loss of fertility of agricultural and forest land call for collective responses that draw on both scientific knowledge and technical skills, as well as many political and ethical aspects.
Acting with the living
The landscapes we inhabit, travel through, and transform (including the soil and subsoil) are in turn inhabited, travelled through, and transformed by other living beings, animals and plants. In his essay Sur la Piste Animale (On the Animal Trail), philosopher Baptiste Morizot invites us to live together “in the great ‘shared geopolitics’ of the landscape”, by trying to take the point of view of “wild animals, trees that communicate, living soil that works, plants that are allies in the permacultural kitchen garden, to see through our eyes and become sensitive to their habits and customs, to their immutable perspectives on the cosmos, to invent thousands of relationships with them”. To interpret a landscape correctly, it is necessary to take into account the “active power of living beings” with their spatiality and temporality, and to integrate our relationship with them.
Acting with other human beings
A landscape is a “collective situation” that also concerns inter-human relations in their various forms. A landscape is linked to desires, representations, norms, practices, stories, and expectations, and it draws on emotions and positions as diverse as people’s desires, experiences, and interests. Acting with other human beings means acting with a complex whole that includes individuals, communities, and institutions, and drawing on the practical and symbolic—in a continuous process of negotiation and mediation.
Acting with space
Considered through the tools of geometry, space is an objective entity: its dimensions, proportions, and boundaries can be satisfactorily described. However, the space of the landscape cannot be reduced to measurable criteria. In reality, it is an intrinsically heterogeneous space: “locations, directions, distances, morphologies, ways of practising them and of investing in them economically and emotionally are not equivalent either spatially or qualitatively”. Interpreting the space of the landscape correctly therefore means remembering that “numerical” and “geometric” measurements are necessarily false, and that the set of geographies (economic, social, cultural, or personal) that make it up are neither neutral, nor uniform, nor fixed in time.
Acting with time
When we think of the relationship between landscape and time, the first image that springs to mind is that of the earth’s crust and the geological layers that make it up, or that of archaeological ruins buried beneath the surface. In short, we imagine a sort of tidy “palimpsest” of a past time, with which all relations are closed. The time of the landscape, however, should be interpreted according to more complex logics: we need only think of the persistence of practices and experiences in its context, and the fact that landscape destruction is never total: rather, it is transformation. What’s more, the time of the landscape also includes non-human time scales, such as geology, climatology, and vegetation. They are temporalities to which we are nonetheless closely linked. Thus, in reality, the landscape remains in constant tension between past and present.
“Our era,” Jean-Marc Besse concludes, “is one of a crisis of attention. […] Landscape seems to be one of the ‘places’ where the prospect of a ‘correspondence’ with the world can be rediscovered […]. In other words, the landscape […] can be seen as a device for paying attention to reality, and thus as a fundamental condition for activating or reactivating a sensitive and meaningful relationship with the surrounding world”, in other words, the necessity of the landscape.
Heidi 2.0
In 1668, Johannes Hofer described a curious physical and mental disorder that afflicted Swiss mercenaries in the service of French king Louis XIV in his medical thesis at the University of Basel. To this ailment, which has as its symptoms a state of afflicted imagination, crying fits, anxiety, palpitations, anorexia, insomnia and an obsessive longing for home, Hofer gave the name “nostalgia”: a term he coined by combining the Greek words nostos (homecoming) and algìa (pain). In later studies, the origins of nostalgia was ascribed to alleged brain damage caused by the sound of cowbells on the necks of grazing cows or to the effect of listening to mountain songs that threw young Swiss men who were far from their native soil into a prostrating state of delirium melancholicum.
The fact that the invention of the word “nostalgia” occurs precisely in the Swiss context is no coincidence: indeed, the Alpine valleys have been suffering a phenomenon of emigration and depopulation since ancient times and on several occasions, with different causes and intensity depending on the historical period. It is only in the post-World War II period, however, that the migratory phenomenon became first customary and then a real haemorrhage. The cities offered more stable employment, independent of weather conditions and seasonality, and a range of services and opportunities unparalleled by life in the valleys and the meagre income from mountain products. Local administrations saw no alternative: the choice was between investing in profitable hospitality activities linked to ski tourism, or depopulation. And with ski tourism came the rapid process of urbanisation that reshaped the mountains.
In the 1960s, therefore, an uncontrolled rush of construction of ski resorts, hotels and second homes began, responding to the conquest of the new dimension of consumption and leisure by the urban middle classes. It is precisely the relationship between the increasingly unliveable city life and the idealised representation of the Alps that drove this movement: Switzerlandalready presented itself to the first British and American tourists in the 19th centuryfrom this perspective, as evidenced by the arcadian atmosphere of Heidi, Johanna Louise Spyri’s novel which was published in 1880 and left a lasting mark on Alpine imagery. While Spyri’s novel took a complex look at the changes in Alpine ways of life as a result of industrialisation, the dominant narrative around the figure of Heidi focused on an unresolved tension between the city and the mountains, portraying Heidi’s life as healthy and “natural” when compared to the one of her sickly cousin Klara, trapped in the artificiality of urban habits. This misinterpretation reflects a distinction between nature and culture that has profoundly damaged the ability to realistically address development models in the Alps.
Alongside the concrete pouring of accommodation facilities, new asphalt roads proliferated, which, as a first consequence, reduced the capillary mobility that for centuries had united the smaller places in the valleys. As Marco Albino Ferrari recounts in his Assalto alle Alpi (Assault on the Alps), “the car, paradoxically, has made the mountains less habitable and more remote. The widespread life on the slopes has been squeezed down along the axes of the main road system, in a linear urbanism where everything must be within reach of the motor. […] The centre becomes the valley floor, next to the regimented river to prevent flooding and reduce the unusable areas of the floodplains. And it is in this mental geography, reversed with respect to previous centuries, that the valley slopes have become increasingly wild, unknown and distant. The mountain internally separates and loses those slope sides. Those mid-altitude spaces that in the indigenous experience constituted the heart of the mountain system become synonymous with high-altitude lands, where the snow allows the playful consumption of the territory vertically.”
Taking a leap forward some fifty years, we realise that the hoped-for redistribution of opportunities and prosperity over the local communities was actually a mirage destined to be reversed within a few years. The ski capitals that polarise the gaze of the general public are but a minority portion of the 6,100 municipalities in the Alps: a handful of names among an often-unknown multitude of towns and villages marked by isolation and oblivion. The depopulation that was to be avoided has taken on the dimensions of a veritable exodus. In some inland valleys, the birth of a child or the relocation of a young couple becomes a news story.

EPFL, École polytechnique fédérale de Lausanne, Alps model, Lausanne, Switzerland. Still from the film Alps. © Armin Linke, 2001.
On the other hand, even the most famous ski resorts are no longer safe. The glacial mass of the Alps has shrunk by 50% since the beginning of the 20th century, snowfall is increasingly sparse, and temperatures are rising. The shifting of the snow line has left the smaller, low-altitude ski resorts in a state of neglect and depression, to which they are still reacting with palliative works such as moving ski lifts a few hundred metres higher up, or the proliferation of artificial snow cannons. If operations of this kind are only palliative measures intended to plug a gap for a few more seasons, we even reach grotesque gestures such as digging a ski trail in a glacier, as recently happened at the Theodul glacier in Zermatt for the Ski World Cup. The crisis in the ski industry is being responded to with outright therapeutic overkill rather than by offering alternatives.
For the past two decades, the economy based on winter sports and or blanc (white gold, i.e. snow) has been going through a crisis, along with urban-based consumption models that underpinned it. A new approach to the mountains is emerging, that of “Alpine minimalism”, which prefers the frugality of the mountain hut and so-called slow tourism in an often anti-modernist key to the high-altitude resort. While this new transformation has the merit of avoiding the dysfunctions associated with the sharp division between high and low season, once again it is a distortion. The appearance of old farm implements on the facades of chalets (not always locally sourced), copper cauldrons hanging in restaurants, traditional clothes to dress waiters, what the anthropologist Annibale Salsa has called “proximity exoticism”, is born, or rather a posturing and anti-technological form of authenticity—Heidi 2.0.
This approach is paradoxical even at a brief glance. In Fragments d’une montagne, Nicolas Nova describes the landscape of Conches, in the upper Valais: “In this corner of the Alps, where the Rhône is still no more than a small river close to its source, the valley is criss-crossed by a host of networks: overhead electricity cables, roads, tunnels and a summit track that is only accessible in summer, the Matterhorn-Gotthard Bahn railway (which carries both passengers and vehicles to avoid the Furka Pass), cross-country ski trails or snowshoe trails studded with orange Swissgas signs indicating the presence of the underground gas pipeline. It’s as if we’re looking at a machine-mountain, with a technical framework that transforms the environment into a productive infrastructure. A Victor Frankenstein-style hybrid of geology and electricity pylons, cavities, rails, dams, bunkers of varying degrees of strength, cable cars, pipes, roads, mobile phone masts and rivers with rectified courses. The mountain-machine, a recurring motif in the Alps, with watercourses, valley bottoms and reliefs covered with all this equipment”.
The anthropization of the Alps is not a new phenomenon: for thousands of years the human species has inhabited this mountain range, ingeniously coping with the scarcity of resources and the complications of life on the slopes, finding specific solutions to coexist in symbiosis with the other species in its ecosystem. Today, due to the thinning out of traditional farming and animal husbandry practices in favour of tourism, the extent of wilderness in the Alps is as great as it was in the Middle Ages. But in spite of this, the balance of the past has broken down, if the public narrative is at the service of those who are convinced that the Alps need to be “valued”—and are not a value in themselves. How can we once again look at the mountains honestly and realistically? How can we return to inhabiting rather than exploiting them? If a path is not walked, it disappears within a short time. The degradation of trails is not caused by overuse, but by oblivion.
Listenting to the Sourdough
An interview on cooperative practices and how to include the more-than-human with Marie Preston, artist and lecturer at the University of Paris 8 Vincennes-Saint-Denis (TEAMeD/AIAC Laboratory). Her artistic work takes the form of research aimed at creating works and documents of experience with people who are not necessarily artists. In recent years, her research has focused on the practice of baking, open schools, and libertarian and institutional pedagogies, as well as on women working in the care and childcare sector.
How do co-creative practices compare with political or social participation?
According to philosopher Joëlle Zask, participation in politics should be a combination of taking part, contributing and receiving. Cooperative artistic practices open up spaces where experiences and opinions can be shared, something which is also common to politics. However, political participation aims for an explicit goal, unlike many cooperative artistic practices which are “indeterminate” at first and whose objectives can change through various encounters. This is very much the plastic dimension of the relational forms that are invented in these practices.
Then there is the fact that these shared experiences are expressed in an artistic, tangible form, which is obviously a key difference compared to exclusively political or social participation. However, there is also another distinctive feature: groups are heterogeneous, and the practice only really works when the singularity of each voice in the collective emerges and reflects the group’s complexity. This is a real asset compared with other forms of participation.
Why did you choose the term “cooperative practices”?
Co-creation is a form of participation in which participants, who form a collective, run an artistic project in a cooperative manner and define from the outset what they are going to do together. The artist does not play a specific role in defining the action, whereas in cooperative practices, the artist is at the origin of the project even before the participants’ subjectivities are involved. In reality, however, it is never that simple: the two modes of participation are closely intertwined.
Given that these are processes that unfold over a long period of time, with different levels of involvement, there are phases where the artist is in charge of the project and others where the group acts autonomously, and vice-versa. There is a form of mobility between the different levels of participation.
Hence, I talk about cooperation, which allows the various voices and subjectivities to come to the fore at different times, rather than co-creation, which leaves less room for positions and functions to change and evolve.
How does the recent awareness of more-than-human communities and subjectivities influence cooperative practices?
Let us take the example of “Levain”, a collaborative research project in which I am involved as an artist and which brings together scientists, peasant bakers, craftspeople who do not produce their own wheat, and bakery trainers.
Our group met to identify the impact of the environment and the history of bakery on sourdough biodiversity. We already knew that the sourdough produced by peasants and bakers was biologically rich, and that this richness was fuelled in particular by the tools and hands of the bakers who handled it. This is a truly sympoietic relationship, to use Donna Haraway’s term. The research consists of finding out how far the sourdough feeds to acquire this important microbial diversity.

Fournil La Tit Ferme, 2022 © Marie Preston
In the course of this research, did the question arise of how to gather the voice of the sourdough?
Absolutely. However, before that, there was a whole process of reflection on how to build a common language between scientists, peasants, bakers, and artists, each of whom have their own specific vocabulary. After that, we tried to define how we related to this living entity. We were all aware that it requires special care. However, we soon realised that sourdough also takes care of us, i.e. that without sourdough, the bread we eat would not have the quality it has. Reciprocity – mutual care, as it were – is therefore very important.
Then we realised that we could not make the leaven talk – it cannot actually speak. Instead, we tried to project ourselves: if sourdough were an animal or a plant, what would it be? In answering this question, each of us tells the story of how we see our own sourdough. The examples given reveal very different relationships: domestication for some, cohabitation or friendship for others. Projecting oneself also leads to forms of anthropomorphisation, which in a way reduces the distance between the person and the sourdough, even if this may appear problematic in certain respects.
Finally, there is the question of how one listens and observes. In the animal world, we talk about ethology as the field of zoology that investigates the behaviour of non-human animals, but we can also speak of plant ethology, which in this case involves paying particular attention to how sourdough reacts. This type of listening focuses on the practice of living things, in this case the practice of baking. The scientific work consists of setting up experimental protocols to understand what some bakers know intuitively. In other words, our aim is not to get the leaven to talk, but to actively include it in our research.
Is the growing interest in participative or co-creative practices linked to the need for new imaginaries? In a changing world, what is the role of co-creative practices?
Cooperative artistic practices enable us to tackle societal and political issues in a different way, to open up our imaginations and to do so collectively. This collective act also helps to combat the feelings of anxiety that are generated when one is alone at home worrying about the climate crisis or the extinction of a species, and to become an actor rather than just an onlooker.
What about the interest shown by institutions?
Institutional interest in these practices is quite present in the criticism of cooperative practices, in that they might be said to contribute to legitimise the disengagement of the State from public services.
The associations or art centres that support these practices can offer a response to this question of instrumentalisation that might help minimise or even prevent it by suggesting that the group itself should be in a position to “invent institutionally”.
In other words, we can work on it by coming up with “counter-institutions”. I believe that cooperative artistic practices – because they are constantly reflecting on their own relational modalities – can also act on the structure that allows them to exist, if they have the will to do so.

Image: Bermuda, 2022 © Marie Preston
Public support for participatory practices, judged in ethical rather than aesthetic terms, is often justified in terms of social impact. What are the underlying risks of this approach?
In 2019, we coordinated a book, Cocreation, together with Céline Poulin and Stéphane Airaud, in which we dedicate an entire chapter to the question of evaluating these practices. Just because a project is funded with the aim of having a social impact or to be exclusively artistic does not mean that it should only be assessed through this filter. Of course, artists are going to want to create art, researchers are going to want to find scientific answers, people in civil society are going to want to have fun, make art, or find scientific answers: it is essential to find ways of evaluating these practices with regard to the implications of the people who make up the group, i.e. ultimately, the evaluation takes place downstream and not upstream. Once again, this raises the question not only of the indeterminacy of the project itself, but also the limits of its instrumentalisation.
Given your experience, what do you think are the important questions to ask yourself at the start of a cooperative practice?
Pedagogue Fernand Oury used to say that the first question to ask yourself when you join a group is: “What am I doing here?” Cooperation puts your own vulnerability to the test: are you ready to question your habits, your ways of doing things, to be challenged by the collective and by all the affects that the collective will bring? Are you prepared to let yourself be carried along by what is going to happen? To accept improvisation? To let go of the control you sometimes feel the need to retain when a subject is close to your heart or when you are emotionally involved in the artistic project?
How can one set up a co-creative practice in a community or territory other than one’s own?
I am very interested in reflexive anthropology, i.e. a form of anthropology that questions its own methods of investigation and its relationship with the people it meets, and above all, that incorporates the subjectivity of the researcher. The most important thing, when working in a new place, with people whose practices you do not know, is to listen, observe, be with the people, and be respectful of their differences, ethically and scrupulously.
Finally, you have to get involved and accept contradiction, which goes back to what we said earlier about the questions you need to ask yourself. I also think it is important not to arrive empty-handed: you have to be generous in your involvement and in every way you can.
Mineral Life
For centuries, the implicit assumption that the mineral realm operates independently from that of life has endured, creating, as in many fields of knowledge, an artificial dichotomy: in this case, between the world of rocks, minerals and crystals – which pertains to geology – and the world of the living – which concerns biology. The understanding of the origin of fossils in the 19th century blurred for the first time the boundaries between the two disciplines, sparking both a scientific and philosophical revolution.
Beyond the gradual replacement of organic matter by minerals resulting in fossils, we now know that the molecules that compose rocks, our bodies and all living things are ultimately the same, and indeed, life is assumed to have arisen because of a geochemical process made possible by the combination of water, air, minerals and energy. Over the past two decades, scholars such as geologist Robert Hazen have highlighted how life and minerals on our planet have in fact co-evolved. Although rocks are perceived as fixed and unchanging entities, especially when compared to the variability of living things, the emergence of life on our planet has actually contributed to profound changes in geology. Indeed, the Earth is characterised by astonishing geo-diversity, estimated to be about ten times greater than that of the other planets in the Solar System, and life has played an essential role in the processes that have led to this differentiation.
A first major breakthrough occurred 2.5 billion years ago with the appearance of a form of photosynthesis in the metabolism of slime algae, releasing oxygen and transforming the atmosphere into an oxidising environment. Oxygen is a corrosive gas that has caused major changes in the minerals of our planet: thousands of specimens, including turquoise and malachite for example, have formed in the surface layers of the Earth’s crust as a result of interactions between oxygen-rich waters and pre-existing minerals. Before the increase in oxygen concentration, such reactions could not have occurred and these changes originated new ecological niches, contributing to the birth and evolution of new life forms.
Another crucial step was the process of biomineralisation: around 580 million years ago, in an evolutionary course that is yet to be fully explained, some animals acquired the ability to develop protective hard parts by exploiting minerals such as calcium carbonate and silica: within a few tens of millions of years, carapaces, teeth, claws, spines, shells and corals became widespread and layered in the sedimentary rocks that now cover a large part of the Earth’s surface.

Image: Marina Cavadini, Oyster, 2022, digital print. Courtesy: the artist and The Address Gallery.
Lastly, among the many examples, let us not forget the formation of the so-called fossil fuels, resulting from the natural transformation, over millions of years, of organic matter buried underground into gradually more stable and carbon-rich forms. Oil, methane and coal have in fact indirectly brought to light how biology and geology are interrelated, due to the fundamental role they play in the Anthropocene, the geological era that we are currently living in. The term Anthropocene emphasises the changes that one living species, namely humans, have and continue to provoke in the planet’s cycles, to such an extent that they have left their mark on the geological record with a speed and severity previously unknown.
In the last decades, the interplay between life and geology has taken a new dimension, especially in the context of technology production and the extraction of rare earths. The demand for these critical elements, which are essential in manufacturing the high-tech devices that now permeate our daily lives, has led to extensive mining operations that impact the ecological balance: the act of writing or reading this very newsletter, for instance, is intertwined with extractivism, a practice and approach that is associated with environmental degradation and human rights concerns. Furthermore, from electric vehicles to solar panels, the technologies that have been proclaimed as unquestionably green solutions to the ecological crisis require the exploitation of components that are once again intensively mined: whether green or not, the capitalistic paradigm perpetuates a cycle of exploitation which is rooted in hyper-consumption and the notion of perpetual growth that is inherent to it. This is why certain scholars opt for the term Capitalocene over Anthropocene, i.e. a critical perspective that questions the way the dominant economic system structures our relationship with the planet.
Reflecting on the balance of life and minerals that has shaped the Earth’s story reveals dynamics that extend beyond traditional geological and biological confines, encompassing economy and society in the broader narrative of the Capitalocene: a way to confront the repercussions of mineral resource extraction and the implications of our role in shaping the planetary course. Recognising our collective trajectory’s entanglement with geological processes prompts a re-evaluation of our relationship with the Earth, demanding a recalibration of our existence with the dynamic forces of geology, acknowledging that the legacy we are forging hinges on a profound understanding of the interconnectedness of ecosystems—where the boundaries between the living and inert soften.
Rethinking Transition
Denise Medico (she, her) is a clinical psychologist and sexologist, and a professor in the Department of Sexology at UQAM. Her research focuses on subjectivity, corporeality, and gender, and on the development of inclusive and affirmative approaches to psychotherapy. She has founded Fondation Agnodice, which works to develop resources for young trans people and their families. She has also co-founded Centre 3, an inclusive feminist training and psychotherapy centre open to all. She is also part of the research group of least’s project Peau Pierre, for which we interviewed her.
Recently, the word ‘transition’ to describe the journey of transgender people has been questioned. Do you also think it is an ineffective term? And why?
Some twenty years ago, before the idea of ‘transition’, there was one of ‘transformation’, and before that, one of pathology: transgender people were considered to have mental issues of which they had to be cured. The ‘transition’ metaphor introduced the idea of a path between two genders, considered as two places. It is a ‘geographical’ metaphor that spoke to many people, including some trans people. These were mostly trans women who had started their transition process quite late in life and who had grown up with binary and even ‘naturalising’ references. In a nutshell, the idea of transition implies going from one gender to another. Thinking about it now, from a more queer, post-Butler* perspective, this is an idea that we are beginning to deconstruct. Genders are social places, grammars, and systems of thought. Gender incongruity is the idea that the ‘place’ you have been assigned is not relevant to your experience. However, if gender is non-binary, then the idea of transition changes too, because inherent in the idea of transition is that of a starting point and an end point. Some people experience it in this way, but the whole process is generally more fluid. A person who has begun this process, who is in the process of change can change direction at any time: the process matters, not the endgame. Moreover, on a political level, at a time when anti-trans movements are very strong, one attack that comes up often is based on the idea of ‘changing gender’. Hence, it is better to talk about ‘gender affirmation’ or ‘gender journey’, not least because we all affirm a gender, whether binary, non-binary, neutral, stable or fluid.
Why is it important to build a vocabulary that is inclusive of trans people? Can you give me an example of a word that would be good to have in everyone’s vocabulary?
While thinking is not based on vocabulary alone, the latter does play a fundamental role. To think of yourself, you need the words to do so. One word that has had a significant impact is ‘non-binary’. There have always been people who felt neither male nor female, that is nothing new, but until now they have never had the possibility to think of themselves in that way. Not being able to think of oneself is a painful experience that leads to depressive, negative feelings. When these people tell you how their life changed the moment they were able to think of themselves with a word, they speak of it as an epiphany: there is a before and an after. The word ‘non-binary’ is a good example, but it is a politically charged word, because it leads to rethinking the whole gender system and the ‘naturalness’ of the male-female hierarchy.
How important is the contribution of feminism in building a vocabulary and the sexual and mental health paths of trans people?
It is not only about transgender people: eliminating these stereotypes affects all people, and if you are ‘different’, it will affect you even more. Things would not be the same today without the history of feminism, without Simone de Beauvoir or Judith Butler. Certain realities already existed, but it was only after they had been conceptualised that they began to change society. Actually, I do not understand why TERFs (trans-exclusionary radical feminists) have a problem with trans people, because by starting from a progressive deconstruction, from the idea that sex is not gender, we produce a much more radical and effective critique of the system that oppresses women by structuring society in a hierarchical way.
Medical technologies are often seen as neutral, and so is science, when in fact they are processes that bring people’s private experience into the public sphere of scientific knowledge and political power and sometimes reinforce forms of oppression. How do medical technologies influence the construction of the trans body, also on the level of imagination? How can medical technologies and pathways be developed that are more effective for trans people?
It is a complex issue. Without medicalisation there would be no trans people, because it was medicine and biomedical research that conceptualised and studied hormones. At the end of the 19th century, the idea emerged that there might be something in the body that determines the male or female gender, leading to the concept of hormones. The history of the transgender movement is linked to endocrinology, but also to psychiatry – both of which were based on a binary vision and worked as ‘gatekeepers’. Today the medical perspective is less binary, but the issue remains complex: hormone therapy, for example, now offers three possibilities, either to obtain the characteristics of one gender, suppress the characteristics of the other, or block the hormones that develop these characteristics. The medicalisation of gender affirmation processes has been debated for twenty years and trans people do not all agree. For now, the position of maintaining medicalisation for economic reasons prevails: if you want to be reimbursed by insurance companies, you have to bow to the logic of health and a diagnosis. Moreover, far-right parties and certain anti-trans movements want to prevent medicalisation rather than control it. Not to mention the medical world, where training is not critical, theoretical, or epistemological, but essentially technical.
Addressing gender issues requires a cross-disciplinary approach. Which disciplines need to be brought together? And how is this interdisciplinarity managed?
Different disciplines of care are involved, although this varies from country to country: in Switzerland, for example, gender affirmation paths are usually followed by a psychotherapist – especially now that they are reimbursed by insurance companies – whose role is to support the person and sometimes report back to the endocrinologist or surgeon. Endocrinologists work with hormone therapy. One specialisation that has grown in importance in recent years is torsoplasty surgery, which, with or without hormone therapy, remains the most popular treatment. Contrary to popular belief, genital surgery is no longer the cornerstone of gender affirmation. Beyond medicine, critical sociology is an important discipline, because when working with trans people, it is important to question what one believes to be ‘natural’.

Aurore Favre, How to crochet a mask, 2023. ©Aurore Favre.
In your experience, is this a good practice? Or are there other specialists who should be involved, or who are involved but should have more space?
It depends: there are different paths that require different approaches. If you were assigned the female gender at birth and feel non-binary, you may want to live without hormone therapy or you may take hormones, often in micro doses, and consult an endocrinologist for advice. You may need surgery: if you cannot stand your breasts, you will need to wear a binder, but they are quite uncomfortable as they compress the ribcage and hinder your breathing, thereby increasing feelings of anxiety. If on the other hand you want to become a transgender man, you might take testosterone. This will change the tone of your voice and your ‘passing’ (i.e. when someone is perceived as a gender they identify as or are attempting to be seen as, rather than their sex assigned at birth) will be perfectly masculine. After just one year of hormone therapy, most transgender people already see noticeable changes. If, on the other hand, you were assigned male at birth and have already gone through puberty, all testosterone-induced changes will not be reversible: for instance, if your voice has already changed, you will not be able to regain a higher-pitched range, and you may feel a greater need for surgery. What’s more, at the moment, because of what is happening politically, people are acting more cautiously: one of the strategies of anti-trans movements is to scare clinicians, sometimes by direct threats, sometimes by filing lawsuits and denunciations with the authorities in order to saturate our time.
And how is this possible, with which motivations?
You can be reported for abusive practices, for example. Even if this turns out to be untrue, you will have put considerable energy into managing the situation. Transgender discourse is rarely visible, if not invisible in public discourse. The practice of ‘passing’ itself counteracts and invisibilises trans identity. That is true, but at the same time we should not think that the trans movement is only made up of politically minded people for whom being visible, asserting an identity, and criticising social structures is possible and desirable. Not all trans people are like that and those who aren’t are not visible, because they do not write or demonstrate. Also, they often have a strong, internalised sense of transphobia, so they try and remain as discreet as possible, because they live in fear. There is a very active non-binary trans movement, particularly in the art world, which is very sensitive to these issues, but which does not represent all trans realities.
I imagine that issues of class or origin, for example, have a part in this.
Education and class play a role. The trans political world is much more present in universities and the arts than in other contexts. It also depends on gender: many transgender people who come out later are people who were assigned male at birth, who suffered trauma as children, and who faced a difficult path before daring to assert themselves. They therefore have a visceral fear of violence from others because they know it well. Hence, they dream of perfect ‘passing’, which is even more difficult for them, because if they have tried to assert themselves later in life, they have already been masculinised by puberty, making ‘passing’ all the more difficult. There are also people with different personality structures, who function differently, cognitively speaking, or who are neurodivergent. Some people, who may be on the autism spectrum as we often hear, tend to think more rigidly, so being ‘normal’ is very important to them. Even if gender is not something that ‘speaks’ to them per se, they look at ‘how it is done’ in society and want to do the same thing.
How important is situated knowledge in the discourse of medical technology and pathway construction? How important is the osmosis of knowledge between trans people and the world of people caring for their sexual and mental health?
There are more and more trans people among us. We are not a cis group, but a very mixed group, and we have worked hard to enable transgender people to access university. When we work from a trans perspective, we have a policy of positive selection – the intentionality is important. As a society, the less we feel obliged to conform to norms, the less trans pathways will be obsessively determined by successful ‘passing’. Instead, we will have a society in which even a trans or non-binary body can exist without countless surgical operations. There are trans people, for example in the art world, who stage their actual bodies, just as there are trans people whose ‘passing’ is completely successful, but who continue to get surgery – perhaps because they are not satisfied with the body they have and are willing to undergo extreme and risky procedures for cosmetic purposes for example. That is also why it is important for some people to undergo psychotherapy, because they will never achieve this ideal – an ideal that does not exist.
Did you find different experiences depending on the contexts, the landscapes, the environments where people live? I was reading a book by Jules Gill-Peterson titled Histories of the Transgender Child and I was struck by the fact that in some rural settings in the US, even very small ones, at times when medicalisation was not an option, trans people managed to have a life that in some way represented their gender.
You cannot separate the idea of ‘passing’ from the idea of social violence; successful ‘passing’ means being invisible so as not to be in danger. The urban-rural opposition is true, but there are many exceptions: in some small communities, there are people who are referred to as that person, who can afford to assert their gender. We conducted a study in a rural area of Quebec on couples in which one person had gone through a gender affirmation process. Almost all the studies focus on couples who were assigned female at birth. These are almost the only studies we have in this sense. They are usually carried out in highly politicised contexts, in cities, with people who go to university and study gender studies. Immigration is also an important factor. For example, in Canada there is a phenomenon of LGBTQIAP+ immigration, but it is complicated: take, for example, a trans woman from the Turkish countryside, where gender perception is extremely binary and the importance of ‘passing’ is dictated by fear, who arrives in Montreal, a queer and non-binary city. Such a person will have the impression of being totally unsuited to Montreal society. You cannot talk about intersectionality without thinking about issues of race but also immigration, social origin, where you are going and where you have come from.
*Passing describes the experience of a transgender person being seen by others as the gender they want to be seen as.
*Judith Butler is a philosopher and gender studies scholar whose work has influenced political philosophy, ethics, and the fields of third-wave feminism, queer theory, and literary theory. Butler is best known for their books Gender Trouble: Feminism and the Subversion of Identity (1990) and Bodies That Matter: On the Discursive Limits of Sex *(1993), in which they challenge conventional, heteronormative notions of gender and develop the theory of gender performativity.
CROSS FRUIT (ex Verger de Rue)
CROSS FRUIT (ex Verger de Rue) is an artistic and urban ecology project created by Thierry Boutonnier and Eva Habasque, that involves citizens in the design, creation and maintenance of an orchard in Onex (Geneva, Switzerland). In this video, director Simon David has gathered footage from the early stages of this project.
Vivre le Rhône: part 3
River Guardians
In July 2023, as part of Vivre le Rhône project, NLC and least organised in Geneva a three days series of events to expand a legitimate community acting on behalf of the river. A video by Carlos Tapia shows how it all unfolded.
Click here for part 1.
Click here for part 2.
Voices:
Maria Lucia Cruz Correia - artist
Marine Calmet - rights of nature
Floriane Facchini - artist / director
Vinny Jones - sensorial scenography
Felix Küchler - doctor, climate activist
Emma-Louise Lavigne - Association id-eau
Gilles Mulhauser Canton de Genève - Office cantonal de l’eau
Laurence Piaget-Dubuis - eco-artist, graphic designer, photographer
The Sacrifice Zone
“One day, at the Ironbound Community Corporation, we smelled something pungent. Wherever you pass over the Ironbound, the main sight will be smokestacles. My whole life, I had smelled this smell. My colleagues said we had to call it in to the Department of Environmental Protection. That was when I started realising that I’ve known that smell my whole life but never thought of it as a problem. That smell made me realise the difference between neighbourhoods like Newark and the suburbs, where there are all these trees and the air actually smells clean. Racial justice has always been a part of my life, but at that moment I realised how insidious environmental racism truly is”. These words were written by Maria Lopez-Nuñez, a Honduran-American activist who has been fighting for years for environmental justice in the Ironbound district of Newark, New Jersey. The neighbourhood is infamously known for its “chemical corridor”, a one-mile stretch where “you pass a natural gas plant next to a sewage treatment facility next to an animal fat rendering plant next to a series of ominous looking chemical storage containers behind acres of fencing. Airplanes pass overhead every two minutes, their engines rattling windows, while a putrid smell wafts from the open pools at the sewage treatment plant.” The area is inhabited by Portuguese, Brazilian, Central American, African American and low-income white people: their fight to “break the cycle of poor communities of colour serving as dumping grounds for our consumer society” is the subject of 2020’s documentary The Sacrifice Zone: Life in an Industrial Wasteland.
The notion of “sacrifice zone” dates back to the Cold War, when the nuclear arms race between the US and USSR left behind a scourge of territories – many of which inhabited –contaminated by nuclear testing and uranium mining. In recent years, the term “sacrifice zone” has been circulating within environmental activism to the point of being included in a major UN report in 2022 “on the issue of human rights obligations relating to the enjoyment of a safe, clean, healthy and sustainable environment”. In this document, sacrifice zones are defined as “extremely contaminated areas where vulnerable and marginalised groups bear a disproportionate burden of the health, human rights and environmental consequences of exposure to pollution and hazardous substances”. But why use the very word “sacrifice”? And the burden that communities have to bear is “disproportionate” to whom?
The issue at stake in these zones is not only the contamination of populated territories but the fact that communities living in these areas pay the price for a form of consumerism and lifestyle that they cannot access and that is enjoyed by privileged groups of people who live in other areas, without having to pay the consequences themselves; a price in terms of health and human rights that mirrors the disparities of class in the globalised world. From the unbelievable levels of pollution due to oil and gas flaring in the Niger Delta, to the unregulated landfills that are spread all over the world, to the emissions of the Ilva steel plant in Taranto, the UN report recounts a widespread and desolating phenomenon that underpins our economic system.

This situation does not, as mentioned, only concern the Global South, but also the weaker communities of the Global North which marginalisation, racialisation and media disregard keep at a distance from any form of protection. The most heavily polluting and hazardous facilities, including open-cast mines, smelters, petroleum refineries, chemical plants, coal-fired power stations, oil- and gas fields, steel plants, garbage dumps and hazardous waste incinerators, as well as clusters of these facilities, tend to be located in close proximity to poor and marginalised communities. When an industry with a heavy environmental impact seeks an area for the construction of a plant, on the one hand it will come up against the “not in my backyard” of the wealthier and more influential communities, while on the other hand it is likely to find acceptance in economically disadvantaged areas due to the promise of job creation and development.
A barrier to opposing these exploitative practices is the fact that soil, water and air contamination and their impact are often not immediately visible. As in Lopez-Nuñez’s account, certain conditions are not perceived as dangerous but rather as normal. Sometimes, people only begin to worry after years of exposure to environmental hazards – when industrial pollution-related diseases start to spread – and it is often too late for reparation. In his book Sacrifice Zones: The Front Lines of Toxic Chemical Exposure in the United States, Steve Lerner describes the feeling of powerlessness of one of these communities: “Once fenceline residents begin asking questions about the extent of the contamination, they frequently report that they get the run-around from officials and are rarely given straight answers or comprehensive information. They often later learn that both government and corporate personnel withheld the bad news about the extent of the contamination out of concern that it might create a panic. This deceitful, paternalistic behaviour makes it impossible for local residents to make timely and informed choices about whether to move immediately (if they can afford to), stop drinking water from wells, keep the windows closed, send their children to live with relatives in other neighbourhoods, prohibit their children from playing outdoors, avoid gardening or eating home-grown vegetables, or take other protective actions”.
The most dramatic contradiction, indeed, lies in the workers’ dilemma between keeping their jobs and risking their own and their families’ lives, or choosing to demonstrate for their rights, risking the relocation of toxic industries to other, perhaps less regulated areas. But both health and salary are needed to survive: unacceptable blackmail that is being played out on the shoulders of the weakest for the welfare of the most privileged. Nonetheless, de-industrialisation, i.e. the progressive reduction of employed people, is a tangible risk, which has left territories such as the Ruhr region in Germany in the grip of structural economic weakness without having initiated effective clean-ups or redevelopment operations – a fate shared by many heavy-industrial areas since the 1980s.
Eventually, Maria Lopez-Nuñez’s tireless advocacy and the collective efforts of the Ironbound Community Corporation have achieved a significant milestone in the fight against environmental injustice. The S232 Bill, hailed as a robust environmental-justice measure, stands as a beacon of progress in safeguarding communities facing intolerable environmental burdens. However, the struggle is far from over, as the insidious, structural nature of environmental disparities persists globally. As outlined in the UN report, “shareholders in polluting companies benefit from higher profits, while consumers benefit through lower-cost energy and goods. Prolonging the jobs of workers in polluting industries is used as a form of economic blackmail to delay the transition to a sustainable future, while the potential of green jobs is unjustifiably discounted. The continued existence of sacrifice zones is a stain upon the collective conscience of humanity”.
The Gesamthof recipe: A Lesbian Garden
Hedera is a collective observation of the overlap between postnatural and transfeminist studies.
Each volume gathers insights related to these topics in the form of conversations, essays, fiction, poetry, and artist content. Hedera is a yearly publication, and its first volume features “The Gesamthof Recipe: A Lesbian Garden” written by artist Eline De Clercq.
The Gesamthof is a non-human-centred garden, it is a garden without the idea of an end result and it is about working towards a healthy ecology. This recipe shares how we garden in the Gesamthof.
Rest, observe.
Start with ‘not a thing’, it is the quietude before one begins. Rest as in ’not to take action yet’. I find this a good begin, it has helped me many times. When I plan to work in the garden I put on my old shoes, take a basket with garden tools and the seeds to sow, and I open the gate and step into the garden and - stop. Not to act at once, but to wait a moment before beginning gives me time to align myself with the soil, the plants, the temperature, the scents, images and sounds. I look at the birds, the snail, the beetle on a leaf. I walk along the path and greet the plants and stones. Like me, in need of a moment, they too need to see who entered the garden. I know the plants can see me because they can see different kinds of light and they grow towards light and they see cold light when I stand in front of them casting my shadow on them. They can see when the sunlight returns and I moved on. This is the first connection with the garden: to think like a gardener-that-goes-visiting. Donna Haraway writes about Vinciane Despret who refers to Hannah Arendt’s Lectures on Kant’s Political Philosophy; ‘She trains her whole being, not just her imagination, in Arendt’s words “to go visiting.”’ all from the book Staying With The Trouble (see the reading list below). Sometimes it is all I do, and time passes, for an hour and more I feel truly alive with listening, feeling, scenting and seeing. I can taste the season.
Your senses & your mind.
To feel as well as to think along with nature. This is perhaps the hardest to explain, but this is the way I learned to garden from when I was helping as a volunteer in the botanical garden in Ghent. While there is a lot to learn and to remember: you can look it up most of the time. There are plenty of books on what kind of plant likes to live in what kind of conditions. Those facts are easy to find. For me, the rational explanation comes in the end, like a litmus test to see if a theory works. I like to begin with experiencing things: feeling the texture of a leaf, noticing the change in temperature when it’s going to rain, comparing soil by rubbing it between your fingers, smelling soil, plants, fungi and so on. Senses connect us to all kinds of matter in a garden and they help one to become part of the garden. Donna Haraway writes about naturecultures, an interesting concept to rethink how we are part of nature and how the dichotomy of nature and culture isn’t a real contradiction. It is an argument to stop thinking as ‘only human’ and start becoming a layered living togetherness. It’s in our best interest to feel nature again with our senses. At the same time, be aware that many plants are poisonous and/or painful, they might hurt you so don’t trust your instincts too much without consulting facts.
Gesamthof, a non-human-centred garden.
The patch of soil I consider as the shared garden, the Gesamthof, is part of a planet full of bacteria, protista, fungi, plants and animals and all of these enjoy being in the garden too. I try to give the fungi some dead wood to eat, and I don’t use herbicides and pesticides while caring for the plants. This is kind of obvious, it’s basic eco gardening, but it also concerns the benefit of the entire garden. The important question is: who is getting better from this? When I count in birds, insects, plants and fungi and the needs they have to survive in a city, then a small garden is for the benefit of all of these and the ruined artichoke isn’t much of a disaster, many big and small gardeners enjoyed being with the artichoke, drinking the nectar, eating the leaves, weaving a web between the dried stalks. Thinking of all us gardening together changes the purpose of the garden, it’s no longer focused on humans only. Often I see a seedmix for bees in the garden centre, but every garden has a different relation to bees, sometimes with solitary wild bees living of a single plant species not having any interest in a human selected seed mix with a colourful flowers display. The question “Who is getting better from this?” stops me buying things for my pleasure and teaches me to be happy when a healthy ecology is establishing.
Thinking like this has made me question the situation of indoor plants. If they could chose between living inside a house in a cold country or being outside in a warm location, wouldn’t they prefer to sense the sunset and feel the wind in their leaves? Am I keeping plants in the house for my own benefit? Would plants grow in my house if I didn’t water them and look after their soil? Should I put plants in places where they naturally wouldn’t grow? I have decided not to buy new plants for in the house, I will care for the ones I am living with as good as I can. Does the garden end at the door? Or do I live in the garden too?

The diversity of city life in a garden.
The opposite of local wild nature is not a foreign plant, but a cultivated plant. The garden combines native plants from many continents, I grow African lilies next to stinzen flowers and local wild plants; they get along well. I’m not a puritan who wants to grow only one colour of flowers or only authentic plants, I see the garden more like a city where we arrive from all corners of the world. Plants don’t know borders, they don’t care for nations, if they like the place they’ll grow happily. But humans don’t always know what they are planting and we build so much & take away so many plants and replace the green in our gardens with other varieties, often cultivars that don’t interact with local species. A cultivar is the opposite of a wild plant, a cultivar is selected for a quality liked by humans but not always in regards to the ecology with other species. Some cultivars are great plants, they are strong and beautiful and interact in symbiosis with the rest of nature. But some cultivars blossom at the wrong time to attract insects, or they don’t provide anything for the others to interact with. In other words, they are planted to be pretty and not to take part of a wholesome nature. Because of these cultivars we are rapidly losing authentic genomes of plants that are important to preserve nature. When you have a garden that is designed and planted with only these kind of cultivars you don’t invite nature in. You might just as well have plastic flowers. The opposite is to care very much for the diversity of ‘pocket’ nature, what was growing in this pocket of the world, and to try to find old species specific for this area that have been around for thousands of years, and have become an important sustainable link within the local ecology of insects, plants, fungi and other living beings. I let the weeds grow in the garden to support the network of insects needing those plants, and birds needing the insects, and local plants needing these insects and birds as well and so on and so on. The gardens in a city are like corridors, they connect insects, plants and fungi into a greater network that is necessary to sustain these species. While we see walls and hedges around a garden, and we might think of it as our island, it is part of a larger green archipelago where plants, birds, insects and others are not hindered by walls. Every city has only one garden made up of all these green islands just a few streets apart.
We shouldn’t break this chain of connected nature by losing our interest in local wild plants, often seen as uninvited weeds and taken for granted, they are very important in a diversity that expands with every living species. Since we’re living in a time of mass extinction & losing multiple species every day, all the things we can do count and in a garden we can let nature in. Sometimes I buy organic local plants from small nurseries to support their effort for conservation. But there is very little money involved in the Gesamthof. When I started to work in the garden I got many plants, seeds and cuttings for free and in return I also like to give away sister-plants so the Gesamthof lives on in other gardens. This is how plants from all over the world became part of the Gesamthof, and they all are very important in the diversity of the garden. There are Spanish bluebells and a Chinese Wisteria that were planted by the monks from the monastery a long time ago, they survived decades of neglect, there are Evening Primroses that most probably arrived on the wind from neighbouring plots and there are colourful tulips, both wild and cultivated that attract all kinds of human and non-human visitors.
The garden will help you.
This is the strangest thing, but since I’m working in the Gesamthof, plants have arrived from all kinds of places, they have often been given to me for free. Also garden materials, pots & books seem to come without much effort. They arrive from lots of generosity from others. I work in the garden, but not to create ‘my garden’, I see the garden as its own entity and I’m ‘the one with arms and legs’ who can help where needed. Many other living things help as well. Wasps have been eating the aphids, Cat’s Foot (Glechoma hederacea) is keeping my path free from weeds and the Titmice eat the spiders that make a web on the garden path (thank you, I don’t like walking into spider webs). I’m one of the garden critters (a word I borrow from Donna Haraway, critter isn’t as attached to creation as creature is) and I love seeing the other critters thrive at their work. I’m not doing this alone. While I do put in a lot of work, I see it as a part of my artistic practice. Gardens are often not seen as an artwork, but to do research, to add a different perspective, to engage with the soil, water and living beings, to build a different kind of place and share this as a public work is very much how I see art work. Art can be more than making and showing things, it can be interaction, awareness and sharing too. The Gesamthof works without a financial set up, it is thriving by generous neighbours who share their plants, seeds, helping hands and advice. This garden is giving more than it costs.
Don’t make a garden design.
This might sound counter intuitive, but being in the garden very often, one should know what the garden needs and that should be enough of planning. The usual garden plan is often seen as to give shape to the idea of an ideal garden, with a sketch of what to plant where, what colours to combine, where the path should be and in what material and so on. It would mean to put oneself above all else as the creator, and it means setting oneself a goal to work towards, with in the end a ‘beautiful garden’. I don’t think gardens should be ‘made’ beautiful, just like women shouldn’t be judged on a scale of beauty. It’s a binary opposition, a way of thinking that leads to a lot of suffering both in and outside of the garden. Instead let the garden take the lead and follow in its steps. You find a plant that likes a sunny area, put it in the sunny part of the garden and it will thrive. Do you have a lot of bare soil in the shady area and you don’t know what to do with it? Look up shady plants, find a nice variety and let it grow in your garden. Do you need a path between the plants? Add the material that works best in that place (for instance a forest kind of material would be tree bark, and recycled materials also make excellent paths). This way you’re growing a cultivated wild garden that will be beautiful all by itself just like nature is. Use creativity in how you arrange stones along a path, in how you support plants that will fall over, in how to add water and feeding stations, in creating fine labels, in making drawings that will later on help you to remember what you planted where… there is lots of room for creativity.

Intersectionality & botany.
The connection between botanical classification systems and people classification systems illustrates how the same mode of thinking is applied to both our gardens and us as people. Botany is full of anthropocentrism and it is not bad to be aware of this, the lesbian garden reframes this use of gardens. Suddenly the invisible norm of who usually benefits from gardens is no longer in place. ‘Lesbian’ means nothing if it is not connected to racialized people, to class differences, to living with disabilities, to age and all the other aspects gathered in Kimberlé Crenshaw’s intersectional theory. To put intersectionalism into practice means asking the ‘other question’: who benefits from this garden?
- Bees opens up the discussion on native plants, their genomes and diversity in gardening.
- Plants opens up the discussion of the colonial past, systems of economics, and who has a ‘right’ to extract.
- An audience that visits art spaces (the Gesamthof is accessible trough the Kunsthal Extra City) opens up the question of class, inviting the ‘other’ in, LGBTQIAP+ friendly spaces etc.
- Me opens up the question of access & responsibility that comes with privilege.
To ask the other question means that we are aware of others. Is the Gesamthof appropriate for children? Should it be? Should we take out all the poisonous plants, the pond, the bees hotel etc if we want children to be safe? There is a fence around the Gesamthof to keep wandering people out, because the garden is certainly not safe for everyone and not everyone is safe for the garden.
Atemporal gardening.
Every place carries a past into its future. The past is not a distant island, it’s very much with us in this thick present (again Donna Haraway’s words, the thick present is like a composted layered presence). In my garden I don’t want to be blind for what is present from the colonial past. It takes effort to find out how all of this is linked, how the history of botanical gardens is woven into to the need for classifying. It is hard work to learn about colonialism and gardening because it’s not as clearly visible as for instance plantations and slavery are linked to cotton and coffee. A garden is often more like a collection of plants bedded into a designed space and the colonial past is not a comfortable topic in garden programs. It takes visiting the past to find out what is here today. For me it meant going to the botanical garden in Meise and looking at the plants brought back from colonies. It also meant digging in the past of the Gesamthof’s location in the monastery, who was gardening here before me? How can I work with ecology towards a better understanding?
Note: People suffer from plant-blindness (J. H. Wandersee and E. E. Schussler, publication ‘Preventing Plant Blindness’ from 1999), it means we don’t see the plants that we don’t know and by giving garden tours one can share the awareness of this cognitive bias. In a lesbian garden the cognitive bias rings a bell, without representation people have a hard time discovering what is different about them. Many lesbians don’t know that they are a lesbian when they grow up, and they see themselves through the norm of a heterosexual society while a part of who they are remains empty for themselves. Like plant-blindness, this abstraction of a norm can be countered by looking at the differences as positive characteristics.
Ongoing change.
A garden is a nice form of art & activism, it is a healthy activity that helps to relieve stress and anxiety. It is working towards change by educating one’s self and each other, it is becoming aware of nature and changing our way of thinking. It is pleasant: the scent, the view, the touch, the sound, it’s a nice place to be. I become very aware of the moment when I sit in the Gesamthof. Time passes differently for all the inhabitants and visitors, and some of us spend a lifetime in this garden (most of the pigeons do) while for me it is very temporary. I will miss the Gesamthof when the new owners arrive in the monastery. But it doesn’t make it less worth it, on a larger scale gardening means ongoing change, and we can enjoy every moment of it. Never is a garden a fixed thing, it is never finished and there is no ‘end’, it just moves into different places.
Stills from Gesamthof: A Lesbian Garden, Annie Reijniers and Eline De Clercq, 2022.

Peau Pierre: an audio capsule
TRAVELING BODY by Jonas Van
In a room in the heart of Geneva, in the middle of the afternoon, our group of artists is meeting. Large quantities of water flood the ground. Collectively, we try to move the water with our bodies. But it flows at a speed we don’t understand; we can’t physically transport it.
The human body has around 100,000 kilometres of blood vessels, enough to circle the Earth two and a half times. Blood vessels are made up of arteries and veins. “Vein” comes from the Latin “vena”: a small natural underground water channel. In fact, by holding the water in our hands, we are imitating the body’s own blood circulation, but outside it.
The water on the ground catalyses our memories. And when our skins finally touch, water is the intermediary in this encounter. This is how a crack in time opens up in this room in the heart of Geneva. Our skins, imitating the movement of the circulatory system, have gradually warmed up to produce enough friction for the water to take the body on a journey through space-time. The next exercise was to talk about where we had travelled. These journeys took the form of audio capsules.
This speculative story is part of the T-T Transition Glossary, a tool designed by Ritó Natálio to develop a form of environmental education that encourages artistic practices as a means of understanding and applying ecological theory to societal challenges. This audio capsule is a work by Jonas Van Holanda, inspired by the Peau Pierre project, workshops, for which he was artist-in-residence.
Peau Pierre: an Audio Capsule by Jonas Van Holanda
Wild Bread
Il pane selvaggio (Wild Bread, 1980) is an essay by Italian philologist, historian and anthropologist Piero Camporesi about the experience of hunger in Europe in the modern age. Hunger in the Global North may appear to be a distant issue, but access to adequate, healthy and affordable food is still affected by profound inequalities both across the world and within single communities.
The “wild bread” to which the title refers describes the bread of the poor, who, to cope with grain shortages in times of famine, began to grind flour from roots, seeds, mushrooms—anything that could fill their stomachs and could be gathered freely on the limited non-private land available. The end product was stale, toxic and non-nutritious bread, which often also caused hallucinatory states.
The educated, rich and powerful men who reported the history of famines had the option of neglecting the experience of the most fragile people. Camporesi has therefore traced the accounts of those who could never aspire to a piece of white bread on their table in folk literature, as in the 16th-century song Lamento de un poveretto huomo sopra la carestia (Lament of a Poor Man Over Famine).

A bad thing is famine
that causes man to be always in need,
fasting against his will,
Lord God, send it away…
I sold the bedsheets,
I pawned the shirts
such that now my uniform
is that of a rag-pedlar,
to my suffering and greater distress
only a piece of sackcloth
covers this flesh of mine.
And even more it pains my heart
to see my child
say to me often, from hour to hour,
‘daddy, a little bit of bread’:
it seems that my soul leaps out
at not being able to help
the little one, oh terrible fate!
A bad thing is famine.
If I leave my house
and I ask a penny for God
all say ‘get some work’,
‘get some work’; oh proud destiny!
I don’t find any, despite all efforts
so I stay with head bent low,
oh fortune, cruel and evil
A bad thing is famine.
I have no more covers in the house
the pots I have sold
and I have sold the pans;
I am clean through and through…
Often my bread is made from
the stems of plants,
In the earth I make holes
for diverse and strange roots
and with that we grease our snouts:
and if there were enough for every tomorrow
it wouldn’t be so bad
A bad thing is famine.
Image: Luca Trevisani, Ai piedi del pane, 2022.
Oplà. Performing Activities, curated by Xing, Arte Fiera, Bologna.
Vivre le Rhône: the podcast, part 03
Vivre le Rhône: a podcast by Audrey Bersier and Martin Reinartz
Dear listener,
Since June 2022, the Natural Contract Lab and least have been deploying practices of walking-with, collective weaving, healing rituals, somatic experiences and restorative circles, all of which have enabled us to rethink our relationship with the Rhone.
What you are about to hear is the final episode in a three-part series, recounting the experiences of those who have grown closer to the river through these walks.
Although this episode marks the end of a collective journey between us and the Rhône, it is not the end of the adventure, because water has no beginning and no end, and the Rhône flows through each and every one of us.
To listen to this podcast, I would like to invite you to connect with water. Head to the bank of your favourite river, walk in the rain, look out at the sea or pour yourself a glass of water and drink it with awareness. Enjoy!

Vivre le Rhône: the podcast, part 03
Listen to part 01.
Listen to part 02.
Vegetaltrout by Maud Abbé-Decarroux.
With texts inspired by Marielle Macé’s Nos Cabanes.
*Every effort was made to obtain the necessary permissions and to trace the copyright holders. However, we would be happy to arrange for permission to reproduce the material contained in this podcast from those copyright holders that we could not reach.
Supported by Fondation d’entreprise Hermès and Fondation Jan Michalski.
Vivre le Rhône: the podcast, part 02
Vivre le Rhône: a podcast by Audrey Bersier and Martin Reinartz
Dear Listener,
Since June 2022, Natural Contract LAB and least have been developing accompanied walks, collective weaving, healing rituals, somatic experiences and restorative circles—all practices that have helped us rethink humans’ relationship with the Rhône.
What you’re about to hear is the first episode of a three-part podcast, retracing the experiences of those who have grown closer to the river by walking.
I’d like to give you a few tips before you start listening to this podcast.
If you can, head to Vernier Village in the Geneva countryside. Take some good headphones with you and your water bottle with water or your favourite herbal tea. Once you’ve arrived, start playing the audio.
You can then walk down to the river and take the Chèvres footbridge, as shown on the map below.

Or you can simply sit down in a spot that you like. And close your eyes.
Enjoy the podcast!
Episode 02
Listen to part 01.
Listen to part 03.
Map by Maud Abbé-Decarroux.
*Every effort was made to obtain the necessary permissions and to trace the copyright holders. However, we would be happy to arrange for permission to reproduce the material contained in this podcast from those copyright holders that we could not reach.
Supported by Fondation d’entreprise Hermès and Fondation Jan Michalski.
Spillovers
Spillovers by Rita Natálio intertwines performance and writing, imagination and somatic experience using transfeminism and ecology as their tools. It is an unusual text, a sex manual, a sci-fi essay on water and pleasure that offers a reinterpretation of Lesbian Peoples: Material For A Dictionary (1976) by Monique Wittig and Sande Zeig.
Spillovers, an excerpt of which follows, represents a glossary defining sensorial and choreography protocols as tools for deciphering and understanding human/non human grafts. Movement is the matter that forms her writing and gathers archives of images and books about ecofeminist theories and practices.
In 2020, a book was found in a well. This well, as many other of life’s cavities, was contaminated by superficial practices of intensive monoculture. Its water, having turned unsanitary, had then dried up for quite a long time. It was inside this hole, then, dried up yet viscerally imprinted by the memory of water, that a translation of Lesbian Peoples: Material for a Dictionary, written in 1976 by Monique Wittig and Sande Zeig, was found. Back then, this book could have been read as a manual or a foundational text for a certain kind of religious cult or spiritual ritual. Much later we learned that it was a diary where the fleeting transformations of transcorporeal and elemental language were recorded, as well as an archive of practices which assembled and connected descriptions of objects, figures, problems and politico-affective strategies that the community of Spillovers (at that time simply called “lovers”, or “lesbian women”, plain and simple) had tried to implement in their lives in the face of the growing aggressions from turbo-capital and the modern science of separations. See, for example, the dictionary entry for Circulation, on page 31 of the English translation:
Circulation
Physical process of intermingling two bodies. Given two bodies full of heat and electricity released from the skin through every pore, if these two bodies embrace, vibrate and begin to mix, there is a circulation and conduction reaction which causes each pore to reabsorb the energy that it had previously emitted in another form. This phenomenon, by the rapid transformation of heat and electricity into energy, produces an intense irradiation from those bodies which are practicing circulation. It is what the companion lovers mean when they say, “I circulate you,” or “you circulate me.”
In the book, one came to understand that lovers perceived themselves as membranes of sorts, seeking to relate to one another through their own ecology of connections and its limits. Yet, in 1976 many of us were only 2 years old or had just learned how to use a ring or a Y-shaped stick to locate water. And the problem was that we did not know whom we meant when we said “we”, as one of us said at the time(1). The plural personal pronoun was a practice that merely allowed us not to disappear into other pronouns that overlooked our lives, even though we did not know exactly who we were.
“Lesbians” or “women” were container-words that seemed inadequate, ill-suited. In 1976, we also knew very little about water-witching, hydrofeminism or the flow of water through different scales, bodies and genders. To balance ourselves on 2 legs was something we could do without a hitch, as was reading, though certain constraints of vision and verticality prevented us from touching the irradiation of energy in more complex ways. The search for water with a stick demanded an initiation, a special care, and the use of the antennae shared by the webs of lovers was a technology not (yet) easy to access.

The glossary presented here proposes a continuity with Wittig and Zeig’s clairvoyance, by elaborating further on the rings and fiction bags(2) that Spillovers must touch and weave in order to tangle the times and produce water. No need to fear getting wet. And much less feeling pain when drinking dirty water, or watching a water-tap blazing with methane gas released from fracking. All these dimensions, painful though they are, organise love among Spillovers. And although at times one can dispense with the centrality of the eyes and reading, images and conversations with indigenous film practices, radical poetry and counter-colonial philosophies are invoked here. They call for simple enough things: that, in the beginning, worlds were created and lived through these references, from Dionne Brand to the Karrabing Film Collective, from Astrida Neimanis to Ursula K. Le Guin. This is the necessary and anti-heroic gesture of 2020: to forget and to cut off all communication with the anthropocenic elites, all the while carrying water for those in need. As a Zen proverb says: “Before enlightenment (…) carry water. After enlightenment (…) carry water.”
GLOSSARY
1. Spillovers
To be a lover means, always, to be a Spillover. The “spill-over effect”, which leads to the spillage of liquids and intentions, is the primary condition for the multi-species and intersex amorous cooperation, whether these liquids are genital, lacrimal or jet-pumped from less obvious parts of the body, such as the elbows or feet. Water is produced at the encounter of 2 or more entities and, if properly placed in bags, it can mutate into the condition of amniotic fluid, which has strong amnesic properties, and can gestate other entities. It is not common for amniotic fluid to be ingested, except when a Spillover is buried under dry soil, a practice that aims to generate water in periods of severe shortage or contamination. Spillovers are all those who, in a life without protagonists, wish to overflow, to spill over and out of themselves, and thus cross the soft borders between peoples, territories and landscapes.
2. Bags
Bags are Spillover technologies with a multitude of functions. Bags can generate and carry babies and can be swapped from body to body regardless of gender. Bags can carry water. Bags can carry amniotic fluid and they can also carry ideas or stories. They are self-healing and biodegradable and yet there is a limit to their use, they are not disposable. Bags do not simply generate human babies, they may also create vegetable or mineral kinship and that’s why one sometimes says that a baby plant or a baby rock was born. Bags also serve as a strategy of resistance in the case of severe groundwater contamination (as shown in the film “Mermaids or Aiden in the Wonderland”, by the Karrabing Film Collective from 2018). In emergency situations, they can break through hard borders such as those that divide today’s nation states. They are tools for the migration or transmigration of bodies which have the temporary ability to deactivate passports.
3. Iris
It is said that a long time ago Spillovers experimented with carrying water, and then experimented with words, in the above-mentioned bags, thus supplying multi-species societies with unexpected and opaque bonds. Since then, whenever the water touches a word inside the bags the latter may split it into pieces: this happened, for example, with the words clitoris (clito-iris) and iridescent (iris-descent), instruments of emotional concentration and unfolding. Since then, when 1 or more Spillovers manage to carry a bag full of water into a territory ruled by monoculture, the Spillover’s iris swells up like a clitoris, thus generating a highly-hydrating golden shower followed by a multicoloured rainbow (an iridescent rainbow) in the sky. This event provides an intense pleasure, but one cannot call it heroic, or confuse it with the male tendency to worship singular phallic figures. In fact, as Spillover K. Le Guin puts it, “…it’s clear that the Hero does not look well in this bag. He needs a stage, a pedestal or a pinnacle. You put him in a bag and he looks like a rabbit, like a potato.”(3)
(1) Adrienne Rich, “Notes towards a politics of location”, 1984.
(2-3) Ursula K. Le Guin, “The Carrier Bag Theory of Fiction”, 1986.
Vivre le Rhône: part 2
Who has the legitimacy to speak for the river?
Vivre le Rhône’s initiator Maria Lucia Cruz Correia, environmental lawyer Marine Calmet and least’s artist-in-residence Martin Reinartz talk about rights of nature and river stewardship. June 2023.
Click here for part 1.
Click here for part 3.
Guardians of Nature
Trained as a lawyer, Marine Calmet specialises in issues relating to the protection of the environment and indigenous peoples. She is also president of Wild Legal, an association dedicated to the recognition of the rights of nature, and the author of Devenir Gardiens de la Nature (Becoming Guardians of Nature), which inspired her battles in French Guiana against illegal gold mines and the oil and gas industry. She is part of Vivre le Rhône’s Natural Contract Lab team.
When it comes to the rights of nature, a question often arises: who is in a legitimate position to speak on behalf of an ecosystem?
I think it’s very much linked to the idea that, in our societies, we have specific roles and statuses. Personally, I like to turn the question on its head. It’s more a question of asking ourselves what we live for and what our mission is in our society. I think that we can all legitimately represent natural entities, quite simply because of the responsibility that comes with living on this planet, in a living environment, and therefore being able to have a more or less strong relationship with a river, a forest or a mountain. For me, legitimacy comes from the bond of empathy, of love even, that exists between us and the environment in which we live and with which we interact. My aim is to deconstruct the myth that we don’t have the legitimacy or the capacity to speak on behalf of nature by asking the following question: what nature are we talking about? Are there not ecosystems to which we are so close and whose interests we feel a responsibility to defend?
What is the role of rights of nature in river governance from your point of view?
The aim of the rights of nature model is to prevent humans from viewing elements of nature as objects, which leads us to objectify our relationship with them and consider all beings around us as exploitable resources and goods that we can also destroy, and from which we can benefit for human progress and for society. The aim is also to challenge this relationship of objectification by considering elements of nature as subjects, legal subjects even, i.e. subjects who are protected or who should be protected and benefit from fundamental rights inherent in their status as subjects. This is where the law comes in, to clarify these relationships which, in truth, for many of us have never really been specified.
The law of nature tells us: “We’re surrounded by subjects to whom we also owe a certain form of respect and with whom interactions must be protected so that the habitability of ecosystems is preserved and this living space of ours remains serene and harmonious”.
In this governance that we’re calling for – this governance of the living – the aim is therefore to integrate other-than-humans, so that, instead of a dialogue strictly between human beings, we can open up the debate to non-humans and integrate them into our models of representation. This will enable us to emerge from what’s known as the Anthropocene – an Anthropocene that is nothing more than human self-segregation – and to integrate non-humans into this governance. This can only be done by recognising nature and all its elements as subjects in their own right and not as objects, because you can’t talk with objects.
You, as a lawyer, cooperate with artists: how can these two seemingly distant perspectives come together in a positive way? How do they impact each other?
What I find fascinating about the interaction between art and law is the similarities that emerge. As a lawyer, I work on what is known as “prospective law”, i.e. law that anticipates the future. I write law, I invent law, based on what I observe in nature and the needs or crises that I observe. As a lawyer, I therefore also work with fiction, writing something that I imagine or that I consider desirable. I’m acting like an artist who projects their vision of the world onto a canvas or a stage, but I’m doing so within a specific circle, i.e. the law. The law, like art, is therefore a set of fictional works that relate to a form of aestheticism. I consider myself to be more of an artist than a lawyer, because I’m in the creative process, a form of free creation that leads me to follow my instincts.
What I really like about working with Maria Lucia Cruz Correia and Natural Contract Lab is that she often points me in directions that I hadn’t thought of, or that I perhaps sometimes tended to think of in too legal a way, too focused on what already exists, on what we call positive law, i.e. what’s already there, instead of thinking outside this framework, taking inspiration and creating differently. Very often, this allows me to make huge leaps forwards in this profession of mine, because it allows me to open doors that I hadn’t imagined.
There’s a very strong link here. Just as artists are capable of thinking things that were previously unthinkable, in the legal world this allows me to make enormous progress. It’s also a way of making the law accessible to everyone, which is more in keeping with the artistic perspective.
It’s also interesting to get a message across. People see what the law is. Sometimes they’re a bit afraid of it and using it in an artistic perspective is an interesting way of linking it to a political context and a vision, that of building a new ideal. So I think there are some really interesting bridges between art and law, particularly through the pleadings we build together. Pleading is rhetoric, and rhetoric is the art of convincing others. Whether in the theatre or in the courts, we’re also here to convince, in a way, and to get our message across. There are inherent, very strong links between artists and lawyers that allow us to mutually enrich one another.
Bodies of Water
The transition of life from water to land is one of the most significant evolutionary milestones in the history of life on Earth. This transition occurred over millions of years as early aquatic organisms adapted to the challenges and opportunities presented by the terrestrial environment. One of those was the need to conserve water: living beings, in a way, had “to take the sea within them”, and yet, although our bodies are composed mostly of it, biological water actually counts for just 0.0001% of Earth’s total water.
Water is involved in many of the body’s essential functions, including digestion, circulation and temperature regulation. Nevertheless, our bodily fluids, from sweat to pee, saliva and tears, are not just contained within our individual bodies but are part of a more extensive system that includes all life on Earth, blurring the boundaries between our bodies and more-than-human organisms, connecting us to the world around us. Scholars described this idea as hypersea: the fluids that flow through our bodies are connected to the oceans, rivers and other bodies of water that make up the planet and are part of a larger system that connects all living beings together.
Recognising the interconnectedness of all life on Earth and the role that water plays in this interconnected web can help us better understand our place in the world and the importance of working together to protect and preserve this precious element. However, to fully grasp the consequences of this perspective, it is necessary to consider some significant issues addressed by scholar Astrida Neimanis, the theorist of hydrofeminism, in her book Bodies of Water.
One of the main contributions of hydrofeminism to the discussion on bodies of water is the proposal to reject the abstract idea of water to which we are accustomed. Water is usually described as an odourless, tasteless and colourless liquid and is told through a schematic and de-territorialised cycle that does not effectively represent the ever-changing, yet situated, reality of water bodies. Water is mainly interpreted as a neutral resource to be managed and consumed, even though it is a complex and powerful element that affects our identities, communities and relationships. Deep inequalities exist in our current water systems, shaped by social, economic and political structures.

Neimanis shares an example explicitly related to bodily fluids. The Mothers’ Milk project, led by Mohawk midwife Katsi Cook, found that women living on the Akwesasne Mohawk reservation had a 200% greater concentration of PCBs in their breast milk due to the dumping of General Motors’ sludge in nearby pits. Pollutants such as POPs hitch a ride on atmospheric currents and settle in the Arctic, where they concentrate in the food chain and are consumed by Arctic communities. As a result, the breast milk of Inuit women contains two to ten times the amount of organochlorine concentrations compared to samples from women in southern regions. This “body burden” has health risks and affects these lactating bodies’ psychological and spiritual well-being. The dumping of PCBs was a human decision, but the permeability of the ground, the river’s path and the fish’s appetite are caught in these currents, making it a multispecies issue.
Hence, even though we are all in the same storm, we are not all in the same boat. The experience of water is shaped by cultural and social factors, such as gender, race and class, which can affect access to safe water and the ability to participate in water management. The story of Inuit women makes it clear how water, even if it is part of a single planetary cycle, is always embodied, and so are bodies of water with their complex interdependence. While hydrofeminism invites us to reject an individualistic and static perspective, it also reminds us that differences should be recognised and respected. Indeed, it is only in this way that thought can be transformed into action towards more equitable and sustainable relationships with all entities.
Neimanis also approaches the role of water as a gestational element, a metaphor for this life-giving substance’s transformative yet mysterious power. Like the amniotic fluid that surrounds and nurtures a growing animal, water can support and sustain life, nourish and protect, and foster growth and development. In this sense, water can be seen as a symbol of hope and possibility, a source of renewal and regeneration that can help us navigate life’s challenges and transitions. Like a gestational element, water has the power to cleanse, heal and transform. While seeking to find our way in a constantly changing world, we can look to water as an inner source of strength and inspiration, a reminder of life’s resistance and adaptability and the potential that lies within us all.
Image: Edward Burtynsky, Cerro Prieto Geothermal Power Station, Baja, Mexico, 2012. Photo © Edward Burtynsky.
Intimity Among Strangers
Covering nearly 10% of the Earth’s surface and weighing 130.000.000.000.000 tons—more than the entire ocean biomass—they revolutionised how we understand life and evolution. Few would probably bet on this unique yet discrete species: lichens.
Four hundred and ten million years ago, lichens were already there and seem to have contributed, through their erosive capacity, to the formation of the Earth’s soil. The earliest traces of lichens were found in the Rhynie fossil deposit in Scotland, dating back to the Lower Devonian period—that of the earliest stage of landmass colonisation by living beings. Their resilience has been tested in various experiments: they can survive space travel without harm; withstand a dose of radiation twelve thousand times greater than what would be lethal to a human being; survive immersion in liquid nitrogen at -195°C; and live in extremely hot or cold desert areas. Lichens are so resistant they can even live for millennia: an Arctic specimen of “map lichen” has been dated 8,600 years, the world’s oldest discovered living organism.
Lichens have long been considered plants, and even today many interpret them as a sort of moss, but thanks to the technical evolution of microscopes in the 19th century, a new discovery emerged. Lichen was not a single organism, but instead consisted of a system composed of two different living things, a fungus and an alga, united to the point of remaining essentially indistinguishable. Few know that the now familiar word symbiosis was coined precisely to refer to this strange structure of lichen. Today we understand that lichens are not simply formed by a fungus and an alga. There is, in fact, an internal variability of beings involved in the symbiotic mechanism, frequently including other fungi, bacteria and yeasts. We are not dealing with a single living organism but an entire biome.
Symbiosis’ theory was long opposed, as it undermined the taxonomic structure of the entire kingdom of the living as Charles Darwin had described it in On the Origin of Species: a “tree-like” system consisting of progressive branches. The idea that two “branches” (and, moreover, belonging to different kingdoms) could intersect called everything into question. Significantly, the fact that symbiosis functioned as a mutually beneficial cooperation overturned the idea of the evolutionary process as based on competition and conflict.
Symbiosis is far from being a minority condition on our planet: 90% of plants, for example, are characterised by mycorrhiza, a particular type of symbiotic association between a fungus and the roots of a plant. Of these, 80% would not survive if deprived of the association with the fungus. Many mammalian species, including humans, live in symbiosis with their microbiome: a collection of microorganisms that live in the digestive tract and enable the assimilation of nutrients. This is a very ancient and specific symbiotic relationship: in humans, the genetic difference in the microbiome between one person and another is greater even than their cellular genetic difference. Yet the evolutionary success of symbiotic relationships is not limited to these incredible data: it is the basis for the emergence of life as we know it, in a process described by biologist Lynn Margulis as symbiogenesis.
Symbiogenesis posits that the first cells on Earth resulted from symbiotic relationships between bacteria, which developed into the organelles responsible for cellular functioning. Specifically, chloroplasts—the organelles capable of performing photosynthesis—originated from cyanobacteria, while mitochondria—the organelles responsible for cellular metabolism—originated from bacteria capable of metabolising oxygen. Life, it seems, evolved from a series of symbiotic encounters, and despite numerous catastrophic changes in the planet’s geology, atmosphere and ecosystems across deep time, has been flowing uninterruptedly for almost four billion years.
Several scientists tend to interpret symbiosis in lichens as a form of parasitism on the part of the fungus because it would gain more from the relationship than the other participants. To which naturalist David George Haskell, in his book The Forest Unseen, replies, “Like a farmer tending her apple trees and her field of corn, a lichen is a melding of lives. Once individuality dissolves, the scorecard of victors and victims makes little sense. Is corn oppressed? Does the farmer’s dependence on corn make her a victim? These questions are premised on a separation that does not exist.” Multi-species cooperation is the basis of life on our planet. From lichens to single-celled organisms to our daily lives, biology tells of a living world for which solitude is not a viable option. Lynn Margulis described symbiosis as a form of “intimacy among strangers”: what lies at the core of life, evolution and adaptation.

Vivre le Rhône: the podcast, part 01
Vivre le Rhône: a podcast by Audrey Bersier and Martin Reinartz
Dear Listener,
Since June 2022, Natural Contract LAB and least have been developing accompanied walks, collective weaving, healing rituals, somatic experiences and restorative circles—all practices that have helped us rethink humans’ relationship with the Rhône.
What you’re about to hear is the first episode of a three-parts podcast, recounting the experiences of those who have grown closer to the river by walking.
I’d like to give you a few tips before you start listening to this podcast.
If you can, head to the Seujet dam, in downtown Geneva. Take some good headphones, writing materials and a bottle filled with water or your favourite herbal tea. Once there, start the podcast.
It’s up to you whether you choose to stay on the dam or walk along the river, towards Pont Butin for example, as shown on the map below.

Or you can simply sit down in a spot that you like. And close your eyes.
Enjoy the podcast!
Episode 01
Featuring texts freely inspired by Corinna S. Bille’s L’inconnue du Haut-Rhone and Les Soeurs Caramarcaz, as well as Alexandre Dumas’ Voyage Suisse.
Map by Maud Abbé-Decarroux.
Listen to part 02.
Listen to part 03.
*Every effort was made to obtain the necessary permissions and to trace the copyright holders. However, we would be happy to arrange for permission to reproduce the material contained in this podcast from those copyright holders that we could not reach.
Supported by Fondation d’entreprise Hermès and Fondation Jan Michalski.
A Sub-Optimal World
Olivier Hamant is a transdisciplinary biologist and researcher at the National Research Institute for Agriculture, Food and the Environment (INRAE) in Lyon, and is engaged in socio-ecological education projects at the Michel Serres institute.
His book “La Troisième Voie du Vivant” envisions a “sub-optimal” future to survive the environmental crisis: in this interview, he promotes the values of slowness, inefficiency and robustness, and invites us to embrace a certain degree of chaos.
Authors and philosophers have always been inspired by the observation of nature to speculate about reality and society, but often with an instrumental approach. You too are inspired by nature, but from your point of view as a biologist, you come to some conclusions that challenge our prejudices on how nature works. How did your questioning begin?
During my PhD I worked on plant molecular biology, looking at genetic control and information. It was a clear example of an industrial framework transposed to biology: we used organigrams, we drew cascades of genes, we discussed “lines of defence,” “metabolic channelling” … Such semantics implied that life is like a machine. When I finished my PhD, I decided to try out a more integrated and interdisciplinary approach to get a more systemic view of biology. This confirmed that what I thought I knew was wrong: I’d been polluted by the concept of living beings as machines, and that’s where I started to deviate.
The book is, in fact, a real lesson in “unlearning,” as you overturn some contemporary concepts that may seem positive but ultimately aren’t, such as “optimisation.”
Optimisation is the archetype of reductionism: to optimise, you first need to reduce a given problem in order to solve it. When we solve small problems, we usually create other issues elsewhere. Take the Suez Canal for example: that’s a form of optimisation, of sea transport here, that makes us very vulnerable. A single boat gets stuck across the canal, and that’s it, you can’t send anything between Asia and Europe.
What about “efficiency”?
Photosynthesis is probably the most important metabolic process on Earth: it has existed for 3.8 billion years, and it’s the root of all biomass and civilisation. The “performance” of photosynthesis is usually less than 1%: plants waste more than 99% of solar energy. They’re really, really inefficient. Plants are green because they don’t absorb all the light; they absorb the red and blue sections of the light spectrum (the edge of the spectrum) and reflect the green part. Why do they waste so much energy? It’s now recognised that this is a response to light fluctuation. Light isn’t stable and capturing the red and blue sections allows plants to face such fluctuations. Plants manage variability before efficiency. They build robustness against performance.
Today, we see that the world is unstable, and it will become more so in the future: we shouldn’t be focusing on efficiency but on robustness. When we look for inspiration from biology, we often focus on circularity and cooperation. It’s a good start, but if we overlook robustness, it won’t work. For instance, if we come up with a form of efficient circularity, we won’t have enough wiggle room for extreme events, and we’ll exhaust the available resources anyway. If we make cooperation efficient, the win-win result will be counterproductive, and some will be left behind. Thus, robustness is the most important principle because it makes circularity and cooperation operational.
The most substantial criticism in your book concerns performance, drawing a parallel between violence against the environment and burnout.
Performance generates burnout—it’s a typical effect. Burnout applies to a person or an ecosystem. The path towards burnout is sufficient to condemn “efficiency at all costs,” but performance is also counterproductive in many other ways. A typical example is sports competitions: you want to be number one, you’ll do anything, including doping or cheating. That has nothing to do with sport and it’s detrimental to your health and career.

You also take concepts we interpret negatively and explain how they are actually positive, such as slowness or hesitation…
Slowness and hesitation are the keys to competence, as might be illustrated by stem cells. Biologists have focused on these cells for a long time because they’re extraordinary: they can renew all kinds of tissues. For a long time, we thought this was all controlled by a tidy organigram. It turns out that one of the key elements is that they’re slow: they hesitate all the time, and because they hesitate, they can do anything. Delays give some breathing space. I would actually go one step further: slowness is an essential lever for transformation. To change, you first need to stop. It’s like being in a car at a crossroads; if you want to change direction, you need to stop, indicate and turn. If you don’t stop, you won’t change.
Change is the keyword here. Hard science, numbers and prediction systems often lack the ability to consider contingencies or change, giving us the illusion that we have some form of control over reality.
Thankfully, we’ve made progress and now we use numbers to understand the unpredictability of the world (instead of using numbers to control it). For instance, in the lab, we’re working on the reproducibility of the shapes of organs. In a tulip field, all flowers look alike. You could think of an IKEA-like process: building things in the same way also makes them replicable. But this isn’t the case for living systems: when a flower emerges, some cells divide, others die, molecules come and go… Basically, it’s a mess. In the end, the miracle is that you get a flower with the same shape, colour and size as the neighbouring one. We showed that the flower uses and even promotes all kinds of erratic behaviours, precisely because they provide valuable information, to reach that reproducible shape. Once again, they build robustness against performance.
So, a certain degree of chaos should be embraced?
Sociologist Gilles Armani once told me a story about how to deal with impetuous rivers. The Rhône has all these swirls: if you don’t know how to swim through them, you might get trapped and drown. When people were used to living with rivers, if caught in the water flow, they wouldn’t fight it: they’d take in some air, let themselves be taken down by the swirl and the river would then let them out somewhere else, until they reached the shore. In a fluctuating world, the aim is no longer reaching one’s destination as quickly as possible, but rather viability, something which should be based not against, but on turbulence.
Image: Boris Artzybasheff.
Learning from mould
Reading
Common Dreams
Peau Pierre
CROSS FRUIT
Faire commun
Arpentage
d’un champ à l’autre / von Feld zu Feld
Learning from mould
Physarum polycephalum is a bizarre organism of the slime mould type. It consists of a membrane within which several nuclei float, which is why it is considered an “acellular” being—neither monocellular nor multicellular. Despite its simple structure, it has some outstanding features: Physarum polycephalum can solve complex problems and move through space by expanding into “tentacles,” making it an exciting subject for scientific experiments.
The travelling salesman problem is the best known: it’s a computational problem that aims to optimise travel in a web of possible paths. Using a map, scientists at Hokkaido University placed a flake of oat, on which Physarum feeds, on the main junctions of Tokyo’s public transportation system. Left free to move around the map, Physarum expanded its tentacles, which, to the general amazement, quickly reproduced the actual public transport routes. The mechanism is very efficient: the tentacles stretch out in search of food; if they do not find any, they secrete a substance that will signal not to pursue that same route.
We are used to thinking of intelligence as embodied, centralised, and representation-based: Physarum teaches us that this is not always the case and that even the simplest organism can suggest new ways of thinking, acting and collaborating.

Putting Off the Catastrophe
If the end is nigh, why aren’t we managing to take global warming seriously? How can we overcome the apathy of our eternal present? The following article is taken from MEDUSA, an Italian newsletter that talks about climate and cultural changes. Edited by Matteo De Giuli and Nicolò Porcelluzzi in collaboration with NOT, it comes out every second Wednesday and you can register for it here. In 2021, MEDUSA also became a book.
There is no alternative was one of Margaret Thatcher’s slogans: wellbeing, services, economic growth… are goals achievable exclusively by doing things the free market way. 40 years on, in a world built on those very election promises, There is no alternative sounds more like a bleak statement of fact, a maxim curbing our collective imagination: there is no alternative to the system we’re living in. Even when we’re hit by crisis, in times of unrest, exploitation and inequality, the state of affairs finds us more or less defenceless. There’s no escape – or we can’t see it: our room for manoeuvre has been fenced off.
Why can’t we take global warming seriously? Because it’s one of those complex systems that operate, as Nick Srnicek and Alex Williams affirm in their Inventing the Future, “on temporal and spatial scales that go well beyond the bare perceptual capacities of the individual” and whose effects “are so widespread that it’s impossible to exactly collocate our experience within their context”. In short, the climate problem is also the result of a cognitive problem. We are lost in the corridors of a vast and complex building in which we see no direct and immediate reaction to anything we do and have no clear moral compass to help us find our way.
It was to pursue these issues further that I decided to read What We Think About When We Try Not to Think About Global Warming (hereafter WWTAWWTNTAGW) by Norwegian psychologist and economist Per Espen Stoknes, a book I’d been putting off reading for some time for a series of reasons that turned out to be only partially valid. First of all, there was my vaguely scientist prejudice: despite being interested in the issue, I find that the back cover of WWTAWWTNTAGW sounds more like front flap blurb for some self-help publication rather than for a serious work of popular science. I quote: “Stoknes shows how to retell the story of climate change and at the same time create positive, meaningful actions that can be supported even by negationists”. Then there was the title, WWTAWWTNTAGW, a cumbersome paraphrase of a title that is already, in itself, the most ferociously paraphrased in the history of world literature. And lastly — still on the surface only – there was the spectre of another book by Per Espen Stoknes, published in 2009, the mere cover of which I continue to find insurmountably cringeful: Money & Soul: A New Balance Between Finance and Feelings.

Laying aside, for the moment at least, the prejudices that kept me away from WWTAWWTNTAGW, I discovered a light-handed book that raises various interesting points. In short: why does climate change, our future, interest us so little? Why do we see it as such an abstract and remote problem? What are the cognitive barriers that are sedating, tranquillizing and preventing us from having even the slightest real fear for the fate of the planet? Stoknes identifies five, which can be summed up more or less as follows:
Distance. The climate problem is still remote for many of us, from various points of view. Floods, droughts, bushfires are increasingly frequent but still affect only a small part of the planet. The bigger impacts are still far off in time, a century or more.
Doom. Climate change is spoken of as an unavoidable disaster that will cause losses, costs and sacrifices: it is human instinct to avoid such matters. We are predictably averse to grief. Lack of practical solutions on offer exacerbates feelings of impotence, while messages of catastrophe backfire. We’ve been told that “the end is nigh” so many times that it no longer worries us.
Dissonance. When what we know (using fossil fuel energy contributes to global warming) comes into conflict with what we’re forced to do or what we end up doing anyway (driving, flying, eating beef), we feel cognitive dissonance. To shake this off, we are driven to challenge or underestimate the things we are sure about (facts) in order to be able to go about our daily lives with greater ease.
Denial. When we deny, ignore or avoid acknowledging certain disturbing facts that we know to be “true” about climate change, we are shielding ourselves against the fear and feelings of guilt that they generate, against attacks on our lifestyle. Denial is a self-defence mechanism and is different from ignorance, stupidity or lack of information.
Identity. We filter news through our personal and cultural identities. We look for information that endorses values and presuppositions already inside our minds. Cultural identity overwrites facts. If new information requires us to change ourselves, we probably won’t accept it. We balk at calls to change our personal identities.
There are obviously hundreds of other reasons why we still hold back from a strategy to mitigate climate change: economic interests, the slowness of diplomacy, conflicting development models, the United States, India, sheer egoism, “great derangement” and all the other things we’ve come to know so well over the years. But Per Espen Stoknes empirically suggests a way forward. Catastrophism and alarmism don’t work. We need to find a different tone to dispel the apathy of our eternal present.
Image: The Grosser Aletsch, 1900 Photoglob Wehrli © Zentralbibliothek Zürich, Graphische Sammlung und Fotoarchiv/ 2021 Fabiano Ventura – © Associazione Macromicro.
A urge to do something
Can you briefly tell us something about you, and how you became an eco-activist?
I wouldn’t say I’m an activist. Apart from my role as co-president, I’m an elected representative in the parliament of my city. I’ve also created an ecofeminist collective with two friends in Biel, called “La Bise”. And I earn my income as an early childhood nurse. Shortly before I turned 18, I felt a strong urge to do something. Or at least to try. I can’t really say what triggered this need to act. I started my political involvement in a small group of young greens. Then one day things just happened. I was asked if I wanted to join an electoral list. I accepted, and I was elected. This event helped me to network and find people with whom I could exchange, militate, and initiate new projects.
What is the state of health of Swiss glaciers? And why is it important to take care of glaciers in particular?
The state of the glaciers in Switzerland is disastrous. With the melting of the glaciers, Switzerland is losing (among other things like its biodiversity and its snow in winter) an important water reserve which, according to estimates, could guarantee the consumption of its population for 60 years.
Part of the resistance to revolutions such as abandoning fossil fuels is linked to economic interests. Let’s play a game of scenarios: with and without fossil fuels, in the short and long term.
Growth can’t be infinite; it leads to our own destruction. Independence from fossil fuels requires support for other forms of energy sources. In Switzerland, electricity is mainly generated by hydroelectric power plants (62%), nuclear power plants (29%), conventional thermal power plants and renewable energy plants (9%). By producing our own energy, we’re no longer dependent on other countries. This is an opportunity for States to become pioneers and create jobs in new areas. So it’s also good for the economy.
Environmental protection is a complex subject – sometimes to fix one mistake you make another. What is your strategy for dealing with this complexity?
I think if you keep thinking about what you’re going to do wrong, you don’t move forward with strategies that have a real impact. You can’t always do everything right. But you can put in place things that have a strong impact for long term change. Like long-term independence from imported energy sources that are harmful to the planet.
Solastalgia is the distress caused by the impact of climate change on people, often involving the feeling of loss of a beloved landscape. Do you feel that you’re suffering from solastalgia? And what’s your experience of this issue in Swiss communities?
Solastalgia is a relatively unknown term. But by talking to people living in wilder and alpine regions, solastalgia for a disappeared or changed landscape can be identified. Sensitivities to climate change are as diverse as the regions of Switzerland. The place of origin of a person influences the way he or she reacts to the consequences of this change. It seems natural to be more affected by the lack of snow in winter or the melting of glaciers if you live or grew up in an alpine environment. People who live in cities, for example, are more aware of urban heat islands and increasing suffocation in summer. At the moment, I think I suffer more from eco-anxiety than from solastalgia.
You’re part of the eco-feminist collective La Bise: can you tell us about the activities of La Bise and what eco-feminist instances contribute in particular to the general fight against the climate crisis?
La Bise is a collective that tries to bring struggles together. The collective was created almost five years ago. Talking with two of my friends about what animated or annoyed us in feminist and ecological struggles, I felt like bringing the three of us together. The idea of creating a caring and inclusive space to talk about our commitments was at the heart of our draft project. At first, we were mobile, we didn’t have a place. Then we were able to create our ecofeminist library. The library contains books in several categories. Feminism and gender, sexuality, children’s books, comics. We have an ecofeminist library, but we also organise more or less regular events that link the fight for the protection of the planet and the fight for gender equality.
Several studies show that women and gender minorities are among the human beings most affected by climate change. To give an example: women and gender minorities are frequently forgotten during natural disasters – often because it is these same people who actually take care of others.
Vivre le Rhône: part 1
“What stories are already there?”
A video by Carlos Tapia featuring the Rhône river, Maria Lucia Cruz Correia, Vinny Jones, and Lode Vranken. February 2023.
Click here for part 2.
Click here for part 3.
Common Dreams Panarea: Flotation School
Common Dreams Panarea: Flotation School is a project that focuses on survival, the commons, and hopes and strategies for addressing climate change and the Anthropocene. The video, crafted by the students at College Sismondi under the guidance of Carlos Tapia, documents the co-creative process led by artist Maria Lucia Cruz Correia, which resulted in the construction of a “floating island” on the waters of Lake Geneva.
GLOSSARY OF TRANSITION (T — T) by Ritó Natálio
Context
People in transition are the sensors of an earth in transition.
Trans people are the radars of Earth’s transition.
Might water be a conductor of contamination?
RADARS OF TRANSITION
They say that “transition is work” and that it should be paid. Reading these words by Harry Josephine Giles (Wages for Transition, 2019), the Immigrant Writer from Southern Europe hopes to make sense of the veiled connection between human bodies thirsting for transformation (and involved in intimate processes of transitioning their assigned gender at birth) and the wider processes of apocalyptic transition of the Earth System (also known as the Anthropocene, or simply “climate collapse”). If transition is work, who would be the bio-proletariat common to these processes? The synthetic hormones administered in hormone therapies, or the hormones released into water sources from the mass use of the morning-after pill? Human bodies or non-human bodies occupied by transitions of all kinds?
And what would be the difference between transition and contamination? What would be the difference between transition as transformation into a new form of life, or transition as degeneration of an existing body? And is this question not a reflection of conservative thinking about a cis-planet or a cis-body, which must be maintained or preserved over time, and to which a transition process would add a good dose of confusion?
On the other hand, is the current process of reducing the socio-biodiversity of the Earth System not a form of protest by the bio-proletariat that highlights the violent conditions of unpaid transition work?
The Immigrant Writer from Southern Europe arrives in Geneva with no common language in which to conduct his research, but he comes with the determination to organise a gathering of young people who could decipher the inaudible and invisible signals of planetary transition, thus helping develop what we have here temporarily called the Glossary of Transition (or simply T — T).
Assisted by somatic specialists – choreographers, visual artists, scientists, and psychotherapists – he sees the signs clearly: pollution is a form of political manifestation of biochemical agents.
The Writer writes in his journal:
5 June 2024: Every time I write in the first person, a ray of light changes or a cloud dissolves. My body is the earth because the earth is my body, and as I scratch my arm, I feel the artery of the Rhône contracting under my fingers. Ever since I started writing about this world, I’ve had the impression of coming from another, a world where levitating and protesting are part of the same reality. So, as I breathe, I show Geneva’s teeth and its monsters: gold ingots from the mines of South America rise from the vaults and fly into the skies above the Jet d’eau. My mouth is made of gold, but I have cavities like all the territories that transit through accumulation. Coloniality is my own body.

Image: Because the Spanish thirst for gold, the Indians poured liquid gold into them, illustration by Theodore de Bry, circa XVI century.
Beware, families, because “endocrine disruptors” attract and deceive your body!
These substances, which disrupt your body’s chemical messages, bind to the receptor and generate an undesirable response!
This was the type of message that appeared in Council of State leaflets in 2004 :
Ladies and Gentlemen,,
On 21 October 2004, the Grand Council referred an urgent written question to the Council of State:
Recent studies and discoveries show that we may be on the threshold of a new and serious water pollution problem.
Abnormally high levels of hormones have been measured in the water, resulting from the discharge into the water of “contaminated” urine and products used that contain hormones, which current treatment plants are unable to neutralise.
The increasingly frequent use of chemical oestrogens for human and animal consumption, pesticides and insecticides, released into the environment, find their way into drinking water, potentially leading to an increase in oestrogen production and hormonal disturbances in humans.
Menstruation at the age of 8, for example, or the infertility of “cis men” have turned out to be frightening consequences that needed to be dealt with as quickly as possible, e.g. by throwing out water contaminated with bisphenol and quaternary ammonium salts, getting rid of all the toys in the house, or burning all your furniture in the public square with the other families affected! So the Immigrant Writer has sought to bear witness in a poem of an experiment in other ways of understanding hormonal chemical messages, in the hope that transition might be embraced as a great experiment in language. Let’s take a look at his journal:
10 Juin 2024: I went to the chemist to buy some testosterone gel and applied it to Geneva’s arm. The water from the melting Alps mixes with the gel, allowing the city’s musculature to transition more smoothly. As if in an embrace, me and G. exchange hormones and dive into a pool of hormonal pollution.

LABELS SHOULD EXIST AND THEY SHOULD HAVE MEANING
Following on from the therolinguistic studies initiated by Ursula K. Le Guin in The Author of the Acacia Seeds (2011) and promoted by Vinciane Despret in Autobiographie d’un Poulpe (2021), the “Peau-Pierre” research team is convinced that language is a haptic, sonic, and also tele-empathic extension between bodies of different shapes. The ability to feel with, and from a distance, enables the Earth body – the T-body – to be mobilised by the empathic transition of other T-bodies and, with them, to communicate through chemical messages of belonging.
In our workshops, many experiments have been carried out to understand the human body as a territory, creating fables and slogans around the idea of the body as a “crumb of time” (Ulysse, workshop Peau Pierre, May 2024, L’Abri) , a “wound” or a “crystal” (Jonas Van, workshop Peau Pierre, May 2024, L’Abri). During one of these experiments, the sensor bodies reported curious episodes such as:
The sensation of transferring hormones through water
The sensation of two spinal columns connected by a zip fastener
The certainty that a shinbone was a tree trunk
Fingers moving like leaves
Hands with a thousand fingers
Little sand creatures revolving limply in the belly of a leg
Flesh goggles where you stick your forehead on a colleague’s forearm
(Contribution from the participants of the Soft Borders Atelier, with Clém, Stella, Ritó and Aurore, July 2023, Theatre Saint Gervais.)
Often, this transfer of qualities between one body and another occurred after a long period of contact with movements, e.g. after caressing a stone for a long time. Crossing and exploring these surfaces, stone and skin would come into contact with each other until their qualities were exchanged.
[To be continued…]


Image: print “Wages for Transition” by Harry Josephine Giles, 2019.
GLOSSARY (possibilities)
HORMONE (Denise Médico)
I’ve forgotten my ritual again, to be done two nights a week, according to the label on the white and pink packaging, a flawless Swiss pharmaceutical design, simple, too straightforward, confident, and almost trivial. I open the bottom drawer and look for the two little plastic tubes that fit together to make a piston-dispenser. I screw it onto the metal tube and pull back the small side to fill the large one with [x] mg oestradiol cream. I put it deep inside my vagina, imagining that it will be more effective, that it will have more time and space to penetrate the tissue and then spread into my bloodstream. I imagine these little animals colonising me and transforming me, sticking to my cells, kissing them with their full mouths, deliberately contaminating them and making them believe that there is still time. Loaded up with my stock of biocompatible synthetic hormones, I slip back into my teacher/psychotherapist envelope.
(Wikipedia, the free encyclopaedia: a HORMONE is a class of signalling molecules in multicellular organisms that are sent to distant organs or tissues by complex biological processes to regulate physiology and behaviour).

Image: Hormonal feedback loop in an adult female. Follicle-stimulating hormone, luteinising hormone, progesterone, oestradiol. Right: Auxin transport from leaves to roots in Arabidopsis thaliana.
TRAVELLING BODY (Jonas Van)
In a room in the heart of Geneva, in the middle of the afternoon, our group of artists is meeting. A large quantity of water has flooded the floor. Collectively, we try to move the water with our bodies. But it flows at a speed we don’t understand; we can’t physically move it.
The human body has around 100,000 kilometres of blood vessels, enough to go around the planet Earth two and a half times. Blood vessels are made up of arteries and veins. “Vein” comes from the Latin vena: a small natural underground water channel. In fact, by taking the water in our hands, we are imitating the body’s basic circulatory movement, but outside it.
This water on the ground catalyses our memories. And when our skins finally touch, water is the intermediary in this encounter. This is how a temporal crack has opened up in the room at the heart of Geneva. Our skins, imitating the movement of the circulatory system, have gradually warmed up to produce enough friction for the water to take the body on a journey through space and time. The next exercise was to talk about where we had travelled. These journeys took the form of a sound capsule.
GLACIER-BODY (Stella Succi)
If I could think the way I should think, I’d find it hard to think: the amount of internal and external stimuli I receive is staggering. To make a comparison, it’s like being in a room where lots of people are talking out loud, all in different languages. In the background there’s loud music, someone’s tapping their foot on the floor above, and on top of that it’s very hot – you’re sweating profusely! How is it possible to do calculations with all this noise? You just can’t! And besides, is it really worth it? So I start listening. That’s my way of thinking. Following the biochemical discourse of the mammoth whose decomposition has stopped between my molecules; or the fallen glove of the distracted mountaineer, dissolving in slow motion like an old cassette in a Walkman with exhausted batteries; and letting myself be lulled by the murmurs of CO2: some come from my most secret depths, almost unconscious, others are young and raging. Recently, a colourful veil of desert sand has also settled over me, with its phosphates, ammonium, and iron… You’ve guessed it: I use the first person singular to make myself understood, but the only pronoun that makes sense to me is they/them.
MOUNTAINEERING (Stella Succi)
Mountaineering was born in the 18th century with the noble aim of mastering the wilderness, even at the most extreme altitudes; of illuminating dark valleys with knowledge; of deflowering the untouched virginity of the mountains (and let’s face it, the mountains enjoyed it too). Moreover, the verticality of the mountains, resembling huge stone erections, seems purposely designed to challenge the most vigorous and powerful men, worthy of looking down on the entire planet. While the first high-mountain expeditions were also guided by scientific interest, modern mountaineering has finally freed itself from this tedious burden to devote itself to simply conquering the summits, at any cost and by any means necessary. As a result, mountaineering has come to incorporate cultural values that define a relationship of domination over a hostile – dare we say hysterical – environment. However, with the glorious advent of the Anthropocene, some mysterious phenomena have been observed, with world-famous climbers coming down the slopes with the strangest symptoms – bouts of coughing, nausea, dizziness, or peeling skin. The effects seem to mimic those of severe intoxication or poisoning: a fact that is inexplicable given the notoriously pure alpine air, always a source of strength and good health. Cases of auditory hallucinations have also been reported: it would seem that some climbers, before experiencing the first troubles, heard a particular noise in the valleys, described by some as an “evil snicker” or a “smug laugh”.
HUMAN WATER-CHAIN (Cyrus Khalatbari)
Extraction
The (geological and computational) human water-chain starts within the labouring bodies and conditions of miners. Take for example the extraction of cobalt – a precious metal used in batteries, hard drives, and printed-circuit boards (PCBs) – in the Democratic Republic of the Congo (DRC): from blood pumping hearts and lungs to sweat and water sachets brought by men and children to sustain their work in open pits or underground mines, the state of our IT culture unravels first in liquid and metabolic ways. In parallel to water as a core element for the survival of labouring bodies, the geological and computational human-water chain also extends to purification and refining processes, with cobalt transformed from ore into “clean” metal. Here, the dual dependence on water is revealed: it is key to extracting labour from miners and for their bodies to function, and it is crucial to craft and transform metal – “polishing” substrates from their raw form to the one that is used in the technological industry and for saving and manipulating data in our daily life.
Optimisation
Love emojis we add to pictures of cute cats or frothy matcha lattes have extensive ramifications. They connect to the tentacular optimisation and cooling infrastructure of data centres. Behind these digital streams which are sorted and organised in visually appealing ways, content is stored, curated, and modelled thanks to a network of water pipelines and thermal control systems. Although the exact location of these facilities is unknown, data is made public about the states in which the computation occurs. For Meta, this is in Arizona, Utah, or New Mexico (USA), where electricity costs rank amongst the cheapest in the country. Despite the aridity of these places, large quantities of water are used. Powering seamless aesthetics that hook us to our social media profiles, natural resources are diverted and exploited. From rivers to lakes, reservoirs and groundwater, technology is liquid on both sides: it liquifies for data control and obfuscation as well as in more literal ways, expanding its infrastructure to water streams and resources to cool down servers.
Waste
In discarded electronics processing sites such as Agbogbloshie (Accra, Ghana), fluids also leak and permute between nature, bodies, and technology. Within the plethora of indigenous techniques which dismantlers, scrap-dealers, or independent smelters use on a daily basis for cleaning, transforming, or recovering these discarded components, water is key. When shredding and crushing devices, water helps, first, by preventing dust and providing “fresh” scavenged metals for buyers. In processes that involve gold and copper, water is also mixed with chemicals and solvents. Workers use wet separating methods to separate the various components: thanks to their density, the metal components sink while plastic and other materials float. Due to the lack of recycling facilities however, water is then discarded into the soil, the groundwater, or nearby rivers. In addition to polluting nature, toxic substances such as lead, mercury, or cadmium leach into nearby water streams. The water is then ingested by animals and cattle before these are butchered and sold in local markets.
COMPUTATIONAL THERMOLABOUR (Cyrus Khalatbari)
Computex 2023, Taiwan
Walking through COMPUTEX, one sees how “the work of computation is the work of managing heat” (Brunton, 2015: 159). Across the different booths that constitute the fair lies a common ground: an accumulation of computer tubes, fans, and other cooling artifacts designed with dynamic lighting systems that gamers can activate remotely. These artefacts, beyond their aesthetic functions, which are characterised by the extensive use of red, green, and blue (RGB) colours, are geared towards one function: circling back to the words of Brunton, they are made to enable chips to compute to their maximum, while dissipating heat in the fastest way, either using air, water, or ice. On the surface, these objects seem merely technical, limited to the realm of computing and the operation of computers. Expanding here from the use of water which is crucial for AI systems and data in our daily lives (see human-water chain), I argue that these objects are also sociotechnical. Put differently, they enact through their needs and characteristics new cartographies of labour, radiating from tech corporations to smaller actors. Fed by our algorithmic desires and needs for ever more powerful and accurate recommendation systems that we assume should “simply work” (Starosieslki, 2016), cooling becomes a core component of the computing economy. With the mastery of thermal optimisation comes algorithmic control, more seamlessness, more dopamine shots, more time spent connecting and consuming. It is at COMPUTEX that liquid nitrogen (ln2) overclocking competitions take place. These consist in pouring ln2 onto the computer’s “boiling hot” silicon chips in order to produce the most powerful gaming setup, in a race against the clock or in a team competition format. Although at first trivial, these competitions are crucial for the industry, since they provide an opportunity to “test” the chips, pushing them to their hot and cold limits under the expertise of liquid nitrogen “overclockers”. With the free labour produced, a transfer of knowledge occurs and is embedded into the next generation of chips: less hackable, more private and “blackboxed”.
Here, I define computational thermolabour as a form of asymmetrical power dynamics at play between tech corporations and individuals. Merging three words (computational, thermal, and labour), the term refers to a situation where powerful corporations of our computational culture exploit and exercise control over users or independent communities based on the thermal characteristics that structure our computational culture.
Agbogbloshie (Accra, Ghana)
This computational thermolabour also determines other parts of our computer’s lifecycles, as in Agbogbloshie in Accra, Ghana. This district, depicted by mainstream Western news channels as the place where “computers go to die” (Wired, 2015), is in fact a vibrant milieu of circularity and transformation. Nuancing these reductive tropes and discourses, places such as Agbogbloshie shed light on local communities working together in extracting value from waste. Here, dismantlers form the first community to activate this chain. Roaming the site’s surroundings, they locate broken-down computers that they buy at minimal prices from vendors. These computers are then scavenged, with their metals sorted (see human-water chain). From copper to aluminium, brass, or steel, the materiality of our sociotechnical culture is then narrowed to the elements that power it. It is then at the level of these metals that the computational thermolabour occurs, mirroring the power dynamics at play at COMPUTEX in Taiwan. More specifically, it arises from temperatures in which these metals melt and transform, enacting in turn different needs for industry and labour. Aluminium, for example, melts at 660.3°C (1,221°F). This enables the metal to be processed by local actors working with indigenous techniques to reach the temperature threshold, generally using air fans to blow oxygens in fire pits. For steel melting at 1,400°C (2,550°F), local dismantling communities depend on facilities owned by Indian corporations. These powerful industry actors operate on larger scales to transform metal scraps into iron rods which are then sold internationally. As the exclusive players in the market of steel processing in Western Africa, they maintain control over pricing, impacting in turn the growth and independence of local communities.
press
Interview with Véronique Ferrero Delacoste about d’un champ à l’autre / von Feld zu Feld
Rhône FM, Good morning Valais, 08/05/2025
Diskussion und Wanderung im Saflischtal
Pomona, 07/08/2025
From field to field: providing space for exchange and conversation
Walliser Zeitung, 07/24/2025
An artistic participatory project
Park Info n.41, April 2025
CROSS FRUIT: Art, ecologie and collective action
Tv Onex, 03/21/2025
Nature morte
Radio GRRIF, 12/18/2024
Sharing authority
Journal de danse - Pavillon ADC, October 2024- February 2025
Art at the table, space of possibilities
L’Hebdo du quotidien de l’art, 07/05/2024
Explore tomorrow, at the heart of public debate
Tribune de Genève, 04/22/2024
Permaculture, the ecological model to reinvent culture
L’Hebdo du quotidien de l’art, 02/09/2024
A floating school to rethink our relationship with the climate and the environment
RTS, 11/29/2023
Becoming a guardian of the Rhône
Le Courrier, 07/20/2023
«Vivre le Rhône», a civic and artistic initiative
Le Temps, 07/07/2023
Weaving Subjects at MACO
«Vivre le Rhône» celebrates the identity of the river
Tribune de Genève, 07/13/2023
The Rhône seeks guardians
Le Courrier, 07/12/2023
An initiative to accompany our society in its transformation
Kunstbulletin 5/2023
least, an association that wants to save the planet through the arts
Forum, RTS, 04/26/2023
«Common Dreams», a floating platform in Geneva
Le Temps, 04/20/2023
A platform on the waves for a better life
Le Temps, 04/20/2023
The association least dreams of saving the planet through the arts
Tribune de Genève, 03/22/2023